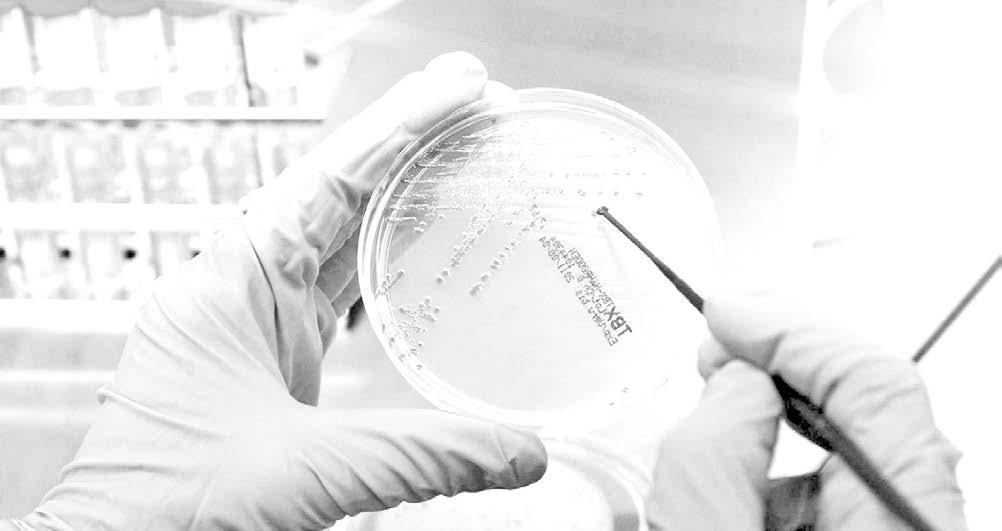

HABRÁ UNIDAD
ENTRE GOBIERNO Y PUEBLO
El 1° de junio de 2O25, vamos a elegir a jueces, magistrados y ministros de la Suprema Corte de Justicia de la Nación, celebró Sheinbaum.


![]()
El 1° de junio de 2O25, vamos a elegir a jueces, magistrados y ministros de la Suprema Corte de Justicia de la Nación, celebró Sheinbaum.


El Congreso del Estado ya autorizó licencia a José Manuel Pozos, para ausentarse del cargo.
CONTINÚA ESCRITURACIÓN DE PLANTELES
El alcalde José Manuel Pozos y la Sindica Beatriz Piña firmaron el instrumento jurídico para un Jardín de Niños.

PREPARAN TORNEO INVERNAL 2024


FUERTES LLUVIAS DEJAN 3 FALLECIDOS

El 1° de junio de 2O25, vamos a elegir a jueces, magistrados y ministros de la Suprema Corte de Justicia de la Nación, celebró Sheinbaum
REDACCIÓN BALANCÁN
La Presidenta Constitucional delosEstadosUnidosMexicanos, Claudia Sheinbaum Pardo, puntualizó que en la Cuarta Transformación el gobierno y el pueblo tienen una gran alianza que se mantendrá y se fortalecerá; esto, desde Balancán, Tabasco, donde se firmó el convenio Pensión Universal para Personas con Discapacidad. “Nos tenemos que mantener muy unidos, gobierno y pueblo. No puede haber divorcio porque, en el momento en que el gobierno mira para otro lado, olvida a su pueblo. Y el pueblo tiene que estar atento también a lo que pasa con el gobierno, también para exigirnos que todo lo que nos comprometimos lo cumplamos. Esa es la gran alianza entre el gobierno y el pueblo de México”, destacó en el evento Pensión Mujeres Bienestar y convenio Pensión Universal para Personas con Discapacidad. Por ello, señaló que lo más importante será siempre escuchar al pueblo, mantenerlo informado, así como ser fieles a su mandato como sucedió con la reforma al Poder Judicial, la cual será una realidad gracias a la elección que las mexicanas y los mexicanos hicieron el 2 de junio de 2024.
“El próximo 1º de junio de 2025 entre todas y todos los mexicanos vamos a elegir a jueces, magistrados y a los ministros de la Suprema Corte de Justicia de la Nación. Ese fue un mandato popular, así lo decidió el pueblo. Ya se votó, ya se publicó en el Diario Oficial de la Federación y la reforma al Poder Judicial va, porque hay que acabar con la corrupción en el Poder


Judicial”.
“Fíjense, nos acusan que somos autoritarios. ¿Lo han oído por ahí, que dicen? Bueno, imagínense, nos acusan de autoritarios porque queremos que el pueblo de México elija al Poder Judicial. Pues eso es democracia, ¿no?, democracia es el poder del pueblo, por el pueblo y para el pueblo. Por eso, somos demócratas, buscamos la libertad y el desarrollo con bienestar de nuestro país”.
Ante las y los tabasqueños, recordó que como parte del segundo piso de la Cuarta Transformación los Programas para el Bienestar se ampliarán con la creación de tres nuevos apoyos: la Pensión Mujeres Bienestar, que en 2025 beneficiará a mujeres de 63 y 64 años, para paulatinamente apoyar a

quienes tengan entre 60 y 64; la nueva beca universal “Rita Cetina”, dirigida en su primera fase, el próximo año, a todos los estudiantes de secundaria, para posteriormente llegar también a estudiantes de preescolar y primaria de escuelas públicas; y finalmente el programa Salud Casa por Casa, en complemento a la Pensión para el Bienestar de las Personas Adultas Mayores, para lo cual ya inició el censo, con la finalidad de conocer el estado de salud de quienes recibirán atención domiciliaria por parte de los 20 mil médicos, médicas, enfermeros y enfermeras que serán contratados a partir del próximo lunes.
Informó que para Tabasco vienen grandes obras y proyectos, como ampliar el Tren Interoceánico para que llegue
ediciontuxpan@hotmail.com
hasta la refinería Dos Bocas; fortalecer el sistema de salud del estado a través de IMSSBienestar con nuevos hospitales; apoyo al desazolve para evitar inundaciones; la construcción de la carretera a Escárcega y de 17 preparatorias, así como dos nuevas universidades: la “Rosario Castellanos” y la Universidad de la Salud; además, 40 mil viviendas y más apoyo al programa estatal de Créditos a la Palabra para ganaderos y acuicultores.
La secretaria de Bienestar, Ariadna Montiel Reyes, celebró la firma del convenio Pensión Universal para Personas con Discapacidad entre esta dependencia y el gobierno del estado, pues de esta manera los recursos podrán llegar a quienes lo necesitan.
“Al tomar protesta en el
Congreso del estado, [el gobernador Javier May Rodríguez] manifestó su intención de adherirse al convenio para que las personas con discapacidad, todos quienes viven en esta condición en el estado de Tabasco reciban esta pensión. Como él ya lo ha dicho, la mitad de la inversión, del recurso, lo va a poner el gobierno del estado y la otra mitad el gobierno que encabeza nuestra presidenta. Hace dos semanas apenas, había ese compromiso por parte del gobernador y hoy lo vamos a hacer realidad”.
El gobernador de Tabasco, Javier May, anunció los nuevos programas y apoyos que se implementarán en el estado, sobre lo cual destacó la creación de Créditos a la Palabra para productores del estado; la ampliación a cuatro carriles de la carretera de Macuspana a Villa Chablé, entre otros proyectos destinados a mejorar la vida de miles de tabasqueños.
También acompañaron a la Presidenta de México al evento Pensión Mujeres Bienestar y convenio Pensión Universal para Personas con Discapacidad: la secretaria de Gobernación, Rosa Icela Rodríguez Velázquez; el secretariodeMarina,Raymundo Pedro Morales Ángeles; la secretaria de Desarrollo Agrario, Territorial y Urbano, Edna Elena Vega Rangel; el secretario de Agricultura y Desarrollo Rural, Julio Berdegué Sacristán; el secretario de Infraestructura, Comunicaciones y Transportes, Jesús Esteva Medina; el subsecretario de Inclusión Productiva y Desarrollo Rural de la Secretaría de Bienestar, Hugo Raúl Paulín Hernández; y el coordinador general de Programas para el Desarrollo, Carlos Torres Rosas.

REDACCIÓN TUXPAN
Como parte del programa “Escuela Garantizada, Escritura Garante”, el alcalde José Manuel Pozos Castro y la síndica única Mtra. Beatriz Piña Vergara firmaron la escritura del Jardín de Niños Frida Kahlo, de la colonia Las Palmas. Estuvieron presentes las regidoras y los regidores Amado Gutiérrez Lima, Anahí Aguilar López, Juan Gómez García, Lucero Reséndis Ambrocio, Luis Demetrio López Marín, comisionado en Educación; y en representación de la Regiduría Segunda, el C.P. Efrén Arrieta Lara. La firma del instrumento jurídico se realizó en la sala de cabildo de presidencia municipal ante el titular de la Notaría Pública Núm. 1, Lic. Luis López Constantino; la Profa. Irma Patricia Alba Guzmán, directora del jardín Frida Kahlo y la Mtra. Inés Hernández García, supervisora escolar zona 114 de preescolar.


“Una de las satisfacciones que hemos tenido es que Tuxpan es uno de los municipios que más escuelas ha regularizado en todo el estado durante la presente administración”, señaló el alcalde José Manuel Pozos Castro.
Mencionó que la escuela cuenta ahora con certeza jurídica para acceder a proyectos de los tres niveles de gobierno, que permitan tener espacios educativos dignos.

Ya cuenta con consultas los sábados y domingos
Para la población que acude a Hospital General de Subzona con Medicina Familiar, IMSS 26 Tuxpan, los cambios en esta clínica son muy notables y están a gusto con ellos, así lo menciona el Señor Juan Carlos Pérez, de la tercera edad y que compara con la atención recibida hace algunos años.
Este nosocomio que dirige el doctor Juan Carlos Quintal Martínez, ya no es el mismo afirmó el tuxpeño, porque dice
“A todos los integrantes del cabildo nos es muy grato hacer entrega de este documento al jardín Frida Kahlo, luego de 32 años de su fundación. El gobierno de Tuxpan seguirá llevando a cabo estas acciones, pues aspiramos a que nuestro municipio sea el primero que termine con el rezago de escrituración”, agregó.
Pozos Castro reconoció el empeño del gobernador Cuitláhuac

que le ha tocado de todo, y el cambio es para bien, ya no hay malas caras y hasta consultas los sábados y domingos. Explicó que hasta llegó a decir sobre las enfermeras que “ellas se sentían las dueñas del hospital, yo le decía mira hija ahí viene la dueña de aquí, porque se enojaba de que uno tuviera que acudir a la consulta y pues así no se podía enfermar uno”.
También refirieron que hay otros programas que se aplican en el Centro de Seguridad Social y eso permite que se complemente los tratamientos, así como el Club Nutricional y otras pláticas que, de acuerdo a los padecimientos de cada persona, están aplicando.
Por ese motivo agradecieron el cambio de actitud del personal, pero también explicaron que hay constantes mejoras, ya que esos cambios son en el personal y la infraestructura, lo que motiva a un ambiente saludable.
García por impulsar este programa en nuestro estado.
Del mismo modo, agradeció al notario Luis López Constantino por el apoyo que ha brindado durante todo el proceso de regularización de instituciones educativas.
De manera emotiva, la alumna Loreli Simonney Cuevas expresó el agradecimiento de toda la comunidad estudiantil del jardín Frida Kahlo: “quiero agradecerles el
MERCADITO
SOLIDARIO
Será en la Plaza Cívica a finales de octubre, de carácter regional
»LIZBETH ARGÜELLES
Tuxpan.- El próximo 27 de octubre a partir de las 8:30 horas, la explanada de la plaza cívica del Ayuntamiento, se convertirá en un punto de encuentro para los amantes de los productos frescos y saludables, puesto que será la sede del cuarto Mercadito de Consumo Solidario.
El mercadito, abrirá sus puertas para ofrecer una amplia variedad de frutas, verduras, hortalizas y productos procesados, todos
apoyo para obtener las escrituras de nuestro plantel educativo, lo cual es un gran logro en beneficio de todos los que asistimos a él y para futuras generaciones”. Por su parte la directora del plantel, Profa. Irma Patricia Alba Guzmán, dijo que con estas acciones se otorga un espacio para sembrar e invertir cultura y educación en las mentes de nuevas generaciones.
ellos cultivados de manera agroecológica y libres de químicos.
Los asistentes podrán disfrutar de los mejores productos de temporada, como frutas cítricas, chiles, maíz, lechuga, plátano, frijol, panadería y mucho más, todo ello, producido por agricultores de los municipios de Tuxpan, Tamiahua, Tihuatlán y la región. Este evento es posible gracias al programa de extensionismo 2024 de la Secretaría de Desarrollo Agropecuario, Rural y Pesca (SEDARPA), bajo la dirección de Evaristo Ovando Ramírez y que, con esta iniciativa, buscan promover la agricultura sustentable y apoyar a los productores locales.
“Invitamos a toda la población a que se sume a esta gran fiesta del campo y el consumo responsable, es una oportunidad única para conocer a nuestros productores, adquirir productos de calidad y contribuir a fortalecer nuestra economía local”, expresó el funcionario.

El lunes 21 no laborarán en el
»LIZBETH ARGÜELLES
Tuxpan.- En un merecido reconocimiento a la labor de quienes día a día contribuyen al desarrollo del municipio, el Ayuntamiento de Tuxpan ha decretado el próximo lunes 21 de octubre como día de descanso oficial, esta medida aplica para todos los trabajadores municipales, sin distinción de base, tiempo fijo o interinos.
La decisión fue confirmada por el Oficial Mayor, Roberto Ávida Moreno, quien destacó la importancia de reconocer el esfuerzo y dedicación de los empleados
municipales.
“Este día de descanso es un pequeño gesto para agradecerles su compromiso con Tuxpan, por ello en acuerdo de cabildo, los dioses determinaron otorgar el día de descanso, suspendiendo labores, reanudándose el martes 22 de octubre en los horarios que ya conocemos”, afirmó el funcionario.
Con este acto, el Ayuntamiento de refrenda su compromiso con el bienestar de sus empleados y busca fomentar un ambiente laboral más favorable, teniendo así un fin de semana largo.
Cabe destacar, que esta acción que considera al lunes 21 de octubre de 2024, como “día de descanso”, en conmemoración del Día del Empleado Municipal, está estipulado en la cláusula 27 inciso e), de las Condiciones Generales de Trabajo vigentes.
Por lo tanto, todos los trámites que requieran efectuar serán hasta el martes de la siguiente semana para que la población tenga conocimiento.




Congreso del Estado ya autorizó licencia a José Manuel Pozos, para ausentarse del cargo
»LIZBETH ARGÜELLES
Tuxpan.- En sesión del Congreso del Estado, de este jueves 17 de octubre, le fue otorgada la licencia al presidente Municipal José Manuel Pozos Castro, para separarse del cargo, misma que abarca del viernes 8 de noviembre de 2024 al 31 de diciembre de 2025, día en que finalizaría su periodo como alcalde. Por lo anterior, a partir del día 8 de noviembre en adelante, la nueva Legislatura, que en su mayoría será de Morena, estaría llamando a Jesús Fomperosa Torres, para que tome protesta como nuevo presidente Municipal de Tuxpan, al ser el suplente del actual mandatario y

al no haber alguna otra propuesta emitida por el Cabildo local. La licencia fue otorgada por el Congreso del Estado por ello José Manuel Pozos Castro dejará el cargo en la primera quincena de noviembre, y mientras tanto se observa haciendo entrega de

LIZBETH ARGÜELLES
TUXPAN
Autoridades municipales invitan a todos los ciudadanos a participar con sus mascotas en el Segundo Concurso de Disfraces, que realizarán el próximo domingo 27 de octubre, puesto que habrá muy buenos premios a los primeros lugares.
A decir de los organizadores, este concurso tiene el propósito de impulsar la convivencia entre las familias
las obras que su administración está realizando en colonias y comunidades, además de hacer la supervisión de las que están en construcción.
Por su parte, Jesús Fomperosa, médico de profesión y actual director de Salud del Municipio, también estaría preparándose para asumir el cargo el próximo mes, en el cual le corresponderá rendir el Tercer Informe de Gobierno en el mes de diciembre y despachar como alcalde todo el 2025, año electoral, en que su desempeño será esencial para la continuidad de la 4T en el gobierno de Tuxpan.

y los animalitos, y además calificarán el entusiasmo a la hora de presentar a la mascota, la originalidad y los materiales utilizados en el disfraz; y premiarán a los tres primeros lugares.
El evento se realizará el domingo 27 de octubre, iniciando a las 17:00 horas con una caminata que parte desde el Puente Tenechaco, hasta llegar a la Plaza Cívica, donde llevarán a cabo el certamen.
Podrán concursar todos los perros, gatos y animales domesticados portando collar y correa, los propietarios deben llevar agua para hidratar a sus animalitos y bolsitas para las heces.
Cabe mencionar, que no aceptarán a animales en peligro de extinción o con restricciones por parte de las autoridades, para proteger tanto a los animalitos como a los propietarios.
Van 13 equipos inscritos y la bolsa de premios a repartir, asciende a los más de cien mil pesos en efectivo
»LIZBETH ARGÜELLES
Tuxpan.- Deportistas Unidos por Tuxpan, afinan detalles para el Torneo de Futbol más esperado del año, el Invernal 2024, donde hasta el momento 13 equipos se han inscrito y la bolsa de premios a repartir, asciende a los más de cien mil pesos en efectivo.
El director general de la organización; Eugenio Hernández Ramos, explicó que hasta el momento estan confirmados 13 equipos
libres, de los cuales 4 son de la rama Femenil y 4 de Veteranos de 40 años y más.
Dijo que tienen contemplado que el torneo de inicio entre el 13 y 15 de diciembre, por lo que la euforia de los ciudadanos será extraordinaria como todos los años, por ello la intención de que los premios sean muy buenos.
“El premio en efectivo es de 100 mil pesos a repartir en los tres primeros lugares de categoría libre, tenemos hasta el momento trece equipos ya confirmados, esperamos que se inscriban dos equipos más de mujeres y un equipo más de veteranos”, informó.
Estas actividades deportivas, sin duda motivan a los todos los ciudadanos y a los participantes para dejarlo todo en la cancha, por lo que se espera que en los próximos días se den a conocer más detalles sobre el torneo, como las fechas exactas de los partidos, los horarios y las sedes.

Vendrán a descubrir la rica historia de la fundación y la cultura de la Huasteca Baja
»URIEL CRUZ
Tuxpan.- El Festival de Vida y Muerte en Tuxpan, está listo para recibir a visitantes y turistas que deseen descubrir la rica historia de la fundación y la cultura de la Huasteca Baja.
El Coordinador del evento
Salvador Cruz Bautista, representante del Centro Cultural de Tumilco, invita a la comunidad a apoyar este evento cultural que busca resaltar las tradiciones y cos-
tumbres de la región.
El Museo Comunitario de Tumilco es un espacio donde se puede aprender sobre la forma de vida de los antepasados, sus artesanías y arquitectura.
Gracias a la donación de la población, el museo ha podido construir una losa de concreto en una antigua escuela, lo que ha permitido revivir el turismo en la zona.
Después de las lluvias y tormentas que dañaron el Museo Comunitario de Tumilco, se ha llevado a cabo una rehabilitación para preservar las 235 piezas arqueológicas y agregar nuevas donaciones, incluyendo dos vitrinas.
La rehabilitación del tejado dañado por el Huracán Grace en 2021 ha sido primordial para el museo.
Salvador Cruz, dijo que, con estas mejoras, se espera un aumento de visitantes para los eventos del 2 de noviembre, donde se podrán explorar las regiones rurales de Tuxpan y obtener una derrama financiera que beneficie a la comunidad local.



Residentes piden se repare la carpeta asfáltica
REDACCIÓN TUXPAN
Se reportan daños en el puente de Tampamachoco, lo cual se teme que ponga en riesgo a vehículos y peatones.
Los baches y grietas en la carretera pueden causar desinflados de neumáticos y, en casos extremos, el colapso del puente, lo que podría provocar la caída de vehículos al río.
Desde febrero de 2022, el antiguo puente está cerrado y la circulación se realiza por el puente nuevo. Sin embargo, la falta de mantenimiento y reparación del puente antiguo ha generado preocupación entre los residentes y conductores.
La comunidad solicita la intervención de las autoridades para reparar las grietas, reemplazar la pavimentación y varillas, y mejorar la inspección de las vías de conexión terrestre para evitar reclamaciones de

daños materiales en el futuro.
La Agencia Municipal de la Mata debe tomar medidas urgentes para abordar esta situación y garantizar la seguridad de los automovilistas y peatones en la zona de Tampamachoco.
La falta de mantenimiento ha llevado a un deterioro progresivo de la infraestructura, lo que pone en riesgo la vida de los usuarios.
Se pide paciencia a los conductores, especialmente al transporte público, particulares y de cargamento, mientras se realizan las reparaciones necesarias.
La seguridad de todos es la prioridad y se espera que las autoridades tomen medidas inmediatas para solucionar este problema.


Señalan pobladores de la ZN la circulación de unidades de carga pesada AGENCIAS
Habitantes de la zona norte de Veracruz denunciaron que la empresa Petróleos Mexicanos (Pemex) no solo contamina, sino que también, daña las carreteras por la circulación de sus unidades de carga pesada.
Se trata de los pobladores de cinco comunidades de Coatzintla, quienes han alzado

la voz y se han manifestado para exigir a Pemex la reparación de los caminos.
La gente reportó que las afectaciones mayores a la carretera Coatzintla-Papantla se localizan en las comunidades Plan de Hidalgo, Plan de Palmar, González Ortega, La Laguna y
Chote.
“Exigimos un trato digno en la reparación de carreteras y caminos para acceso a nuestros pueblos, introducción de agua y programas de vivienda digna”, increparon.
La más reciente protesta fue ayer jueves sobre la carrete -

Retiran basura y escombro de campo deportivo
AGENCIAS
TIHUATLÁN
La directora de ecología y medio ambiente, Nancy Trinidad Rocha, dio a conocer que se continúa con las acciones en el cuidado del medio ambiente, principalmente con la limpieza y mejora de la imagen en los espacios públicos de comunidades.
Acompañada del conocido tihuateco Edwin Leobardo Gómez Ortiz y la directora de turismo Silvia Uribe, se ubicaron en el campo deportivo de la comunidad Enrique Rodríguez Cano (Zapotalillo), donde retiraron basura y escombro en sus áreas, además de proceder a pintar una barda, lo que permitirá una zona cómoda para practicar el deporte.
En tan importante actividad se contó con el apoyo de los alumnos del telebachillerato comunitario de esta localidad, quienes trabajando en conjunto pudieron avanzar en el retiro de la basura, logrando así un espacio digno para los habitantes.
“Sin la ayuda del alcalde y del joven entusiasta Edwin Leobardo Gómez, esta actividad no se podría concretar como sucedió en la limpieza del arroyo del ejido Lázaro Cárdenas y el avance en la campaña de reforestación que se realiza en el municipio”, precisó.
ra mencionada. Los lugareños amagan con bloquear ahora hasta las plataformas petroleras ubicadas en esas localidades en caso de que Pemex no atienda sus reclamos. Cabe recordar que hace unas semanas los vecinos de Ojital Viejo, Papantla, denunciaron
El objetivo es mejorar la calidad de vida
AGENCIAS PAPANTLA
Pensando en mejorar la calidad de vida, el alcalde Bonifacio Antonio Sosa, dio el banderazo de arranque de la ampliación de la red eléctrica en Manantiales.
un derrame de hidrocarburos en el arroyo de la localidad, lo que causó la muerte de especies y contaminó la región.
Mencionaron que Pemex no atendió debidamente el problema, lo que ha generado un problema mayor y daños irreparables al medio ambiente.
Las familias beneficiadas serán los del sector Los García, el munícipe, Bonifacio Antonio Sosa, dialogo en compañía de la síndica y el regidor y dieron inicio a estos trabajos que por años los habitantes estaban esperando.
Antonio Sosa, indicó que con este arranque se refrenda el compromiso de trabajar por que las familias cuenten con los servicios básicos y que con la electrificación se elevará también la calidad de vida. “Seguiremos trabajando para fortalecer nuestra infraestructura tanto en las comunidades como en la cabecera municipal”, expresó Bonifacio Antonio. Por su parte los vecinos agradecieron a la primera autoridad por tomarlos en cuenta y cumplir con sus necesidades que será benéfico para las generaciones futuras.

Primera Sección
AGENCIAS BOCA DEL RÍO
Leonardo Cornejo Serrano, con trayectoria en Petróleos Mexicanos como director de Proyectos Industriales en la filial Pemex Transformación Industrial y quien coadyuvó en la construcción de la Refinería de Dos Bocas, será el titular de la Secretaría de Infraestructura y Obras Públicas (SIOP), anunció la gobernadora electa de Veracruz, Rocío Nahle García.
Igualmente, nombró al Ing. Marco Antonio Beltrán Virgen a la Subsecretaría de Infraestructura e Ing. Víctor David Palacios Gutiérrez a la Subsecretaría de Obras
Públicas y Comunicaciones de la SIOP.
Cornejo Serrano es Ingeniero Químico con estudios de maestría y doctorado en el Instituto Tecnológico de Celaya, en su trayectoria cuenta con la participación en varios proyectos de gran importancia para Petróleos Mexicanos como las reconfiguraciones de las refinerías de Tula, Salina Cruz y Minatitlán, la construcción de los complejos de procesamiento de gas de Burgos y Arenque y la moderni-
“Necesito un constructor y ejecutor con experiencia.”, afirma la gobernadora electa

zación del centro petroquímico
La Cangrejera.
“Leonardo Cornejo tiene un doctorado en Ingeniería de Procesos y de Construcción, está en la dirección de Proyectos de Petróleos Mexicanos, ha hecho muchos proyectos, tiene una
amplia experiencia, pero lo más importante es un ejecutor inmediato, es decir, trabaja con ejecuciones aceleradas.”, destacó.
La gobernadora electa de Veracruz también dio a conocer
como próximo Procurador de Medio Ambiente del Estado, al Ing. Químico, Ángel Carrizales López, exdirector Ejecutivo de la Agencia de Seguridad, Energía y Ambiente (ASEA) dependencia de la secretaria de Medio Ambiente y Recursos Naturales
(Semarnat)
Es Ingeniero Químico egresado de la Instituto Tecnológico de Ciudad Madero, Tamaulipas, con especialización en materia Ambiental.
En el sector de Hidrocarburos se ha desempeñado como técnico especialista en las áreas de calidad ambiental, operacional, seguridad e inspección técnica en la refinería de Francisco I. Madero en Tamaulipas. También trabajó como especialista en el activo Ku Maloob Zaap ubicado en la Sonda de Campeche. Asimismo, como Subsecretaria de Cambio Climático y Gestión Ambiental de la SEDEMA, a la actual alcaldesa de Soledad de Doblado, Arantxa Zamitiz Sosa, de profesión Ing. en Energía y Desarrollo Sustentable.

»AGENCIAS
Xalapa.- El paro de trabajadores del Poder Judicial de la Federación (PJF) continúa en el estado de Veracruz, en rechazo a la reforma judicial que establece la designación de jueces, magistrados y ministros a través del voto popular.
A nivel nacional se acordó reanudar las actividades el pasado miércoles; sin embargo, en Xalapa sigue la inconformidad de los trabajadores.
De acuerdo con Monserrat de Alba, integrante del PJF, este viernes por la tarde se determinará si el paro de labores continuará la siguiente semana.
“Evidentemente, este paro sigue siendo con atención de casos urgentes. ¿Qué casos se consideran urgentes? Cualquier cuestión que tenga que ver con privación de la libertad, fuera de cualquier procedimiento, es decir, que te detengan sin razón aparente. Cuestiones que ten-

gan relación con salud, cuestiones que involucren a menores o a mujeres en situaciones de violencia. Todo eso se ha seguido atendiendo hasta el día de hoy y, de hecho, el trabajo no ha sido menor en los juzgados de distrito”.
Se trata de más de 800 personas que laboran en las sedes del Poder Judicial de la Federación en la capi-
tal veracruzana. La suspensión de labores sigue en las sedes del PJF en los municipios de Xalapa, Emiliano Zapata y Villa Aldama. “Sí, sigue con base en las circulares de las coordinaciones, o sea, magistrados y jueces de aquí de Xalapa decretaron. Xalapa, Emiliano Zapata y Villa Aldama, que seguía el paro jueves y viernes todavía,

Llega programa contra adicciones
De la SSP a 300 escuelas este año
AGENCIAS
XALAPA
Con el programa de prevención de adicciones, la Secretaría de Seguridad Pública han alcanzado a la comunidad estudiantil de 300 escuelas de nivel bachillerato y secundaria, informó el director de Vinculación Institucional de dicha dependencia, Eleazar Guerrero Barrera.
En entrevista refirió que estas signifi-
can alrededor de 400 acciones que van dirigidas a la prevención de adicciones, consecuencias del delito e información de salud.
“La Secretaría de Seguridad Pública asume el compromiso en el tema de adicciones, que, aunque es un tema de salud, nosotros llevamos información de primera mano, sobre todo de las consecuencias que hay del consumo de la droga, transportar la droga e informarles a todos ellos (estudiantes)”.
Destacó que cuando a un alumno se le platica de las consecuencias que ocasiona el consumo de metanfetaminas, cocaína, empiezan a tener respeto al tema.
“A veces es lo que les falta a los jóvenes que les digan cuál es la consecuencia en su salud, pero también la consecuencia social y como ellos fortalecen la cadena criminal y las consecuencias jurídicas”.

miércoles, jueves y viernes. Y ahorita están deliberando, la Asociación Nacional de Jueces Federales, de juzgadores federales, hoy van a emitir una votación que se cierra a las seis de la tarde y a partir de ahí veremos qué hacemos”. Recién se dio a conocer que una jueza federal, con sede en Veracruz, dio un ultimátum de 24 horas a la
Exigen una investigación ante posible caso de investigación
»AGENCIAS
Xalapa.- Pobladores protestaron y bloquearon la carretera federal Xalapa-Veracruz, a la altura de la localidad Plan del Río, municipio de Emiliano Zapata, lo que generó un gran caos vial en la zona.
La mañana de este viernes 18 de octubre, los habitantes se concentraron frente a los negocios de esta localidad, donde mostraron pancartas para defender a dos docentes de telesecundaria “Adolfo López Mateos”.
“Justicia para los maestros de nuestra secundaria. Fuera Ruby Ronzón, no la quere-
presidenta Claudia Sheinbaum y al director del Diario Oficial de la Federación (DOF) para eliminar la publicación del decreto de la reforma judicial.
Nancy Juárez Salas, Jueza del Décimo Noveno Juzgado de Distrito en Veracruz, señaló que si las autoridades no atienden este plazo pueden incurrir en un desacato judicial.
mos en el pueblo”, se leía en sus mensajes.
Las personas exigieron a esa mujer y su hija que se vayan de la comunidad, pues son conflictivas y ahora están acusando a los profesores de abusar sexualmente de los alumnos, sin tener pruebas y sin fundamento.
“Acusan a un maestro del lugar de violación, el profesor solo les invitó un café en la escuela, exigen una investigación por parte de las autoridades correspondientes”, increparon los quejosos.
Los habitantes amarraron una cuerda de un extremo a otro de la carretera federal libre Xalapa-Veracruz, cerrando ambos sentidos de la vía de comunicación.
Con ello se vieron afectados los negocios de la zona dedicados a la venta de frutas y comida en Plan del Río.
El bloqueo carretero se derivó del conflicto escolar por personas que hicieron acusaciones falsas contra los profesores de dicha telesecundaria.
La carretera federal fue liberada después de las 12:00 horas de este viernes en dicha zona del municipio de Emiliano Zapata, una zona cercana a la capital veracruzana.

XALAPA

La Ley de Amparo no aplica para reformas constitucionales, por lo que las que se aprobaron recientemente del Congreso de la Unión, incluida la del Poder Judicial no pueden ser revertidas por una o por cien jueces, aseveró el diputado federal Eleazar Guerrero Pérez. En entrevista, cuestionado en torno a la suspensión definitiva contra la reforma judicial que otorgó la jueza Nancy Juárez Salas, del Décimo Noveno juzgado de Distrito en Veracruz, que ordenó al Diario Oficial de la Federación y a la presidenta Claudia Sheinbaum Pardo retirar la reforma del Diario Oficial. El legislador de la Bancada de Morena en el Congreso Federal recordó que dicha jueza enfrentará una denuncia interpuesta por el Gobierno Federal por abuso de poder y explicó: “La Ley de Amparo no aplica para reformas constitucionales
y la Constitución, bien claro, en el artículo 135 dice quién tienen las facultades para hacer las reformas constitucionales y esas reformas no son sujetas a la Ley de Amparo”.

Día a día se llevan a cabo medidas específicas para otorgar los tratamientos que lo requieran
AGENCIAS
XALAPA
En el marco del Día Mundial de la Lucha contra el Cáncer de Mama, el Instituto Mexicano del Seguro Social (IMSS) en Veracruz Norte realizó un Lazo Rosa humano, en seguimiento a la campaña ¡Te toca! Tú 1+1, con el lema:
“Una mujer y una más sumado contra el cáncer de mama”. En la realización del Lazo Rosa, participó personal de todas las Jefaturas y Coordinaciones de la Representación. Es mediante el Programa PrevenIMSS, que se llevan a cabo actividades de promoción y educación para la salud, que incluyen la capacitación en autoexploración mamaria mensual en mujeres de 20 en adelante, la exploración clínica anual en mujeres a partir de los 25 años y la toma de mastografía cada 2 años en mujeres aparentemente sanas de 40 a 69 años. Para el IMSS en Veracruz Norte es una prioridad la atención oportuna del cáncer de mama, por lo que, día a día se llevan a cabo medidas específicas para otorgar tratamiento a nuestras mujeres mexicanas que lo requieran.

Destacó que no es la primera vez que se enfrentan a cascadas de amparos contra la Reforma al Poder Judicial, incluso antes de la aprobación en el Congreso de la Unión,
No es necesario esperar 72 horas para denunciar casos de privación de la libertad de menores
AGENCIAS COATZACOALCOS
No es necesario esperar 72 horas para denunciar casos de privación de la libertad de menores, aseveró Belén Santiago Escobedo procuradora de protección de niños, niñas y adolescentes del DIF de Coatzacoalcos.
Lo anterior lo dio a conocer tras la localización de Juan Jaret de 2 años este
donde amenazaron con dar cárcel a los diputados que votaran a favor de la misma.
“Todos estos personajes han vivido así, han sido unos violadores consuetudinarios de la Constitución y ahora quieren continuar así. No hay revés de que se echa abajo. No, por supuesto que no. O sea, ¿cómo va a estar un juez o una jueza o diez o cien jueces por encima del pueblo, la mayoría del pueblo de 36 millones de mexicanos?”, criticó. En ese sentido, Guerrero Pérez señaló que desde la campaña para el proceso electoral de este año se hizo de conocimiento de los electores la propuesta de la Reforma Judicial, conocida con Plan “C”, por la que la gente votó a favor.
jueves por la noche.
“En este caso en toda carpeta de investigación que este una alerta amber, regularmente nos hacen el llamado, es importante aclarar que la alerta amber no te llega por boletín, debe haber una carpeta de investigación de por medio y es la fiscalía la que la activan”, indicó. Precisó que en casos como los del menor se debe actuar de manera inmediata ante las instancias correspondientes.
Respecto al caso del niño, agregó que el DIF fue notificado de su localización y por eso acudieron al punto, sin embargo, es la Fiscalía la que hará las indagatorias pertinentes.
“Ahorita nosotros estamos a la disposición como es fiscalía a la disposición que nos digan para acompañar el protocolo, los servicios que les integra el DIF”, mencionó.
En tanto personal del organismo asistencial estaría presente para el protocolo y hacer la entrega a sus padres.

»AGENCIAS
Coatzacoalcos.- Aunque se separe la basura, el problema sigue siendo el confinamiento final de los desechos, refirió la activista de Coatzacoalcos Tania Maldonado Antonio.
Y es que consideró que se podrá dividir los residuos, sin embargo, cuando llegan del punto de recolección al camión vuelven a mezclarse llegando a tiraderos a cielo abierto como el de Villa Allende o basureros clandestinos.
“En terrenos baldíos, ahí también estamos perdiendo la conciencia como ciudadano, como habitante el que yo vaya y tire la basura en un terreno baldío claro que nos puede afectar, al final debemos ser conscientes todos, yo como generador de residuos lo puedo separar para disminuir la cantidad de residuos que llega al camión de basura y por consiguiente disminuye la cantidad de basura que llega al basurero a cielo abierto”, precisó.
La directora de Ecokaans, insistió

que la población puede separar los residuos que tengan sustancias químicas como botes de gas refrigerante o aerosoles, pero cuando van al camión de la basura se revuelven. Dijo que no hay manejo adecuado de diversos residuos en la ciudad,
complicando la situación.
“Los spray, thinner, qué usamos en casa, spray, muse, el spam para cocinar, todo lo que es para pintar, pegamentos sin clavo, resistol, pinturas para las tareas de los niños, todos esos químicos mezclados,

Este viernes, el presidente municipal Ricardo Ahued Bardahuil asistió al Informe Bimestral de Presidencia del Consejo de la Cámara Nacional de Comercio, Servicios y Turismo (CanacoServytur) Xalapa.
Durante la reunión, el presidente de la Cámara, Carlos Arturo Luna Gómez entregó un reconocimiento al edil por el trabajo realizado en dos Administraciones Municipales.
Dijo que Xalapa ha tenido cambios considerables en la estructura física y
social.
“Recibió una ciudad abandonada, en la que se dejaron de realizar muchas cosas, y posteriormente se empezaron a hacer obras de transcendencia”, agregó.
Expuso que se ha visto una mejora urbana, así como la recuperación de los espacios verdes.
Además, integrantes de diversos comercios externaron sus peticiones al edil, con el fin de realizar cambios en la región en temas de vialidad, turismo, deporte y el cuidado del agua. El edil refrendó su compromiso de mantener diálogo y comunicación con todos los sectores, así como atender y realizar acciones en favor de la comunidad.
Asistieron el alcalde suplente Alberto Islas Reyes, el regidor Carlos Ortega Murguía, y representantes del empresariado local.

claro que pueden hacer una explosión.
O sea, aunque tú separes plásticos, papel, cartón, latas, que es lo que se puede procesar, el vidrio dónde lo podemos llevar, los electrónicos, todo el químico qué traen los electrónicos no los podemos procesar y las empresas no vienen a Coatzacoalcos”
adornarán distintos
»AGENCIAS
Xalapa.- En el invernadero “El Haya” de la dirección de Medio Ambiente de Xalapa se producen alrededor de diez mil plantas de cempasúchil para adornar distintos espacios públicos de la ciudad durante la celebración de Día de Muertos y Todos Santos.
Por su color, el cempasúchil se relaciona con el sol y en los pueblos prehispánicos se creía que comunicaba a los vivos con los muertos a través de su aroma.
“La especie que estamos manejando ahorita es, la que hemos manejado comúnmente es la tagetes erecta, cempasúchil. Algunos
Lo anterior lo dio a conocer luego de que durante la semana explotaron unos botes de gas para los climas y refrigeradores al momento de que fueron compactados por un camión en Villa Allende.
sitios muy específicos como los puentes, el puente Rébsamen, la avenida Murillo Vidal, algunas partes del parque Juárez” Hombres y mujeres plantan la semilla y cuidan el crecimiento de esta simbólica planta cuyas semillas maduran justo cuando florece, en esta temporada y no cuando se marchita como otras plantas.
“La ponemos a germinar el 24 de junio, la variedad grande y la variedad pequeña que es esta, la ponemos el 15 de julio para posteriormente empezarla a envasar a principios de agosto y darles un tratamiento a las fechas para sacarlas a las áreas”.
Esta peculiar flor de cempasúchil comenzó a producirse de esta forma desde hace 16 años, luego de que fue encontrada una planta de esta especie en la avenida maestros veracruzanos. desde entonces se mantiene la semilla y cuida su crecimiento con los cuidados y fertilizaciones para que las calles de esta “la ciudad de las flores” el amarillo y naranja de la flor de 20 pétalos esté lista para la fiesta de día de muertos y todos santos, a finales de octubre e inicios de noviembre.


En un esfuerzo por equilibrar la percepción de inversionistas mexicanos y extranjeros, hace unos días se abrió una mejor comunicación entre la administración de Sheinbaum y el empresariado doméstico e internacional.
El evento Diálogos CEOs México-Estados Unidos, organizado por el Consejo Coordinador Empresarial y la US Chamber of Commerce de la mano del titular de Economía, Marcelo Ebrard, logró reunir a cerca de 240 ejecutivos de ambos países y dejó un buen ánimo entre los asistentes, colocando la agenda de Sheinbaum en temas diversos que hace meses traen inquietos a los mercados.
El mensaje fue una bocanada de oxígeno para algunos hombres del dinero que desde hace varios años fueron maltratados en las formas, mas no necesariamente en el fondo por el pasado gobierno.
La imagen logró disipar algunas dudas latentes, sin embargo, el saldo del encuentro no es garantía ni un cheque en blanco para la nueva administración. Hay nubarrones importantes en la esfera económica, legislativa y de (in)seguridad.
Mientras Sheinbaum informaba de la importancia del Estado de derecho y de confianza para las inversio-

¿ESTADOS UNIDOS VA TRAS LOS FACILITADORES?
MARCELA GÓMEZ ZALCE
nes en el país, el discurso de la presidenta y sus líneas de acción se desarrollaban en una suerte de paralelismo contradictorio a lo que sucedía en el circo legislativo entre caos y bolitas que se hacían bolas en un circo dantesco. En un entorno extremadamente desordenado se llevó a cabo la tómbola para la elección de jueces y magistrados, exhibiendo una imagen que en nada abona a la percepción de certidumbre para los mercados.
La propuesta en el citado foro de llevar a cabo mesas de trabajo en los diferentes temas que preocupan a la esfera empresarial es una buena estrategia para fungir como diques de solución de problemas y resolución de conflictos –sí, solo si– hay coordinación y comunicación entre todas las dependencias. De nada servirá si en esos espacios no están sentados los titulares para enfrentar las inquietudes, demandas y solicitudes de la cúpula empresarial. Las palabras de Suzanne Clark, presidenta y CEO de la US Chamber of Commerce fueron claves para entender el ánimo de nuestros vecinos al expresar que “. nuestra relación no se basa sólo en la proximidad, se basa en valores compartidos; el valor de la democracia, la libre empresa y el Estado de derecho.”
El asunto de fondo alrededor de este encuentro fundamental es que el T-MEC ya está en la mesa de análisis.
¿UNA OPORTUNIDAD PARA LA PAZ O UN NUEVO CAPÍTULO DE INCERTIDUMBRE?
SOLANGE MÁRQUEZ
“Me quedé con Fakhri y empecé a interrogarlo. Le agarré la garganta con una mano y empecé a ahogarlo, y con la otra mano le di un puñetazo en el estómago, entonces de repente tuvo un ataque al corazón y murió”. Estas palabras, pronunciadas fríamente por Yahya Sinwar durante un interrogatorio en 1989, describen el asesinato de Fathi Issa, un palestino sospechoso de colaborar con Israel.
Esta anécdota escalofriante ilustra la brutalidad del hombre que, décadas después, se convertiría en el líder de Hamas. Considerado uno de los artífices detrás del sangriento ataque del 7 de octubre de 2023 contra Israel, Sinwar ascendió a la cúspide de la organización terrorista en agosto de 2024, tras el asesinato de Ismail Haniyeh en una operación israelí en Teherán el 31 de Julio.
Más de un año después de ese fatídico día que dejó más de mil 200 israelíes muertos y cientos de rehenes, Israel ha confirmado la muerte de Sinwar en una operación militar en Gaza, marcando un giro dramático en este devastador conflicto.
Su eliminación que es vista por muchos como un acto de justicia, podría abrir nuevas vías para negociar el cese de hostilidades y la liberación de los rehenes que aún permanecen cautivos en Gaza. Pero al mismo tiempo representa un nuevo capítulo de incertidumbre porque su ausencia crea un vacío de poder en Hamas que podría desencadenar luchas internas por control de organización. Entre los posibles sucesores se encuentran Mohammed Sinwar, hermano de Yahya Sinwar y uno de los comandantes más veteranos del brazo armado de Hamas. Otro candidato potencial es Khalil al-Hayya, miembro del Buró Político de Hamas y uno de los principales negociadores del grupo en Doha. También se menciona a Khaled Mashal, un antiguo alto funcionario de Hamas, como posible opción para el liderazgo. Mashal, que no ha vivido en los territorios palestinos desde los 11 años y divide su tiempo entre Doha y El Cairo, podría ser más susceptible a
la presión externa que Sinwar, lo que potencialmente abriría una vía para las negociaciones. Sin embargo, su influencia en Gaza, donde no tiene control sobre los combatientes, es incierta.
La sucesión presenta desafíos significativos. Ninguno de los candidatos parece tener la misma influencia o experiencia que Sinwar en ambas alas de Hamas, la política y la militar. Esta falta de un liderazgo unificado podría complicar las negociaciones futuras y potencialmente poner en mayor riesgo a los rehenes israelíes.
Además, el nuevo liderazgo podría adoptar una postura más radical o, por el contrario, más abierta a negociaciones. Esto tendría implicaciones no sólo para el conflicto con Israel, sino también para las relaciones de Hamas con actores regionales como Irán y los países árabes.
Desde el punto de vista del gobierno de Netanyahu, se podría ver la eliminación de Sinwar como una oportunidad para declarar victoria y concluir la operación militar en Gaza, aunque Bibi ha reiterado su determinación de continuar hasta lograr la liberación de todos los rehenes y el desmantelamiento total de Hamas.
La muerte de Sinwar, sin embargo, podría desencadenar un caos peligroso. Ante un liderazgo débil, podríamos presenciar una reacción virulenta por parte del brazo armado de Hamas, lanzando ataques más feroces contra Israel o poniendo en peligro la vida de los rehenes.
Paradójicamente, la eliminación de Sinwar podría tener un efecto positivo inesperado en Gaza, pues su liderazgo extremista y perjudicial para los propios palestinos podría abrir la puerta a un liderazgo más moderado o pragmático, potencialmente mejorando las perspectivas de Gaza a largo plazo.
La muerte de Sinwar marca un momento decisivo, pero el desenlace de esta guerra aún está por definirse. Las próximas semanas serán fundamentales para determinar si este acontecimiento conduce hacia la paz o desencadena nuevas oleadas de violencia.
México enfrentará un escenario adverso frente a Estados Unidos y Canadá. En 18 días es la elección presidencial y nada está dicho todavía tanto para los republicanos como demócratas.
Lo cierto es que ambos tienen como prioridad en su agenda el tema de la inseguridad que azota regiones enteras de México donde además es visible el cogobierno con el narco y sus secuelas los tienen profundamente inquietos.
No es casualidad sino causalidad el mensaje enviado por el juez Brian Cogan con la sentencia contra García Luna y su doble vida;”. compatibilizando su papel en una entrañable familia con otro como facilitador de una gran empresa criminal.”.
El precedente de esta frase en este juicio —más lo que se sume del delincuente Zambada y exsocios— debería encender todas las alertas en la esfera política mexicana, donde sobran los actores facilitadores que han hundido al país en un abismo de impunidad y violencia.
Y todos esos personajes y la interminable red de vínculos, sin lugar a duda, pasarán a la báscula de la justicia estadounidense.

“Miente, miente, miente, que cuanto más grande sea una mentira, más la gente creerá. Una mentira repetida mil veces se convierte en verdad”, dijo Joseph Goebbels, ministro de propaganda del partido Nazi. Lo anterior se conoce como “ilusión de verdad” en psicología.
En los últimos seis años, con aterrador incremento (y usted no me dejará mentir), existe la percepción de que la mentira no sólo se volvió cotidiana, sino de nulas consecuencias o riesgos para el mentiroso. Y es que, contagiados por la ligereza con que se escucharon una y otra vez, cada mañana, insultos, descalificaciones, negativas, amenazas, ataques, otros datos y negaciones de información oficial, nos sentimos con la licencia para mentir, como mentía públicamente la máxima figura política del país.
A quienes mienten se les olvida que, tarde o temprano, serán descubiertos. En ocasiones, da mucho coraje; no la mentira, sino la inocencia de quién miente y cree que no será descubierto... ¿O más bien será que, hoy en día, lo de menos es que se compruebe una mentira?
Fernando Gago, el exdirector técnico de Chivas y hoy de Boca Juniors, negó categóricamente sus arreglos con el club argentino, cuando existían múltiples
MENTIRAS
FÉLIX FERNÁNDEZ
pruebas de su inminente arreglo. No lo aceptó en entrevistas previas y posteriores al clásico tapatío, no lo aceptó ante sus jugadores y, hasta el día de su partida, no fue capaz de emitir siquiera una despedida o comunicado. Lo más increíble de toda esta novela, es que tenía una cláusula de rescisión que se podía pagar en cualquier momento, para dejarlo libre contractual y legalmente; sin embargo, prefirió la mentira y negación. Es decir, optó por la mentira sobre la verdad. Durante el partido México vs Valencia en Puebla, un muy conocido narrador de televisión se envalentonó ante la pésima exhibición que daba el Tri en la cancha y, de plano, se dirigió a las autoridades de la FMF para reclamar el veto que le querían imponer en los partidos de la Selección Nacional... Mentira. El narrador no volvió a hablar del tema. El día del México vs Estados Unidos, de pronto las redes se inundaron con la noticia de que Javier Aguirre había sido ingresado a un hospital de urgencia. Incluso, que había sufrido un desmayo. Al salir de la clínica (no hospital), el propio vasco notificó que había ido por un chequeo de su espalda recién intervenida. Así que los rumores, una vez más, mentiras.

Cantante fue sorprendida junto a un futbolista del Club América
AGENCIAS MÉXICO
La mañana de este viernes 18 de octubre la cantante, Karol Sevilla se robó las portadas de los medios del entretenimiento después de que saliera a la luz un video que la relaciona sentimentalmente con un futbolista del Club América, el equipo más ganador del futbol mexicano. A sus 24 años de edad, Karol Sevilla se ha consagrado como una de las jóvenes más influyentes en el mundo del espectáculo gracias al trabajo que ha realizado como
actriz y cantante. Además su vida amorosa es otro aspecto que llama bastante la atención de sus millones de sus seguidores. Hace unas horas el periodista de espectáculos, Pablo Chagra compartió un video en el que asegura que la cantante, Karol Sevilla fue sorprendida junto a un futbolista del Club América. Al parecer la cantante y el deportista intercambiaron varios besos durante un ensayo de ella. En este sentido el colaborador del reality show de “La Casa de los Famosos México” aseguró que Karol Sevilla fue sorprendida junto

a Diego Monroy, futbolista del Club América. Al parecer el jugador acompañó a la cantante a uno de sus ensayos de su próxima presentación y aprovecharon para demostrar que están más enamorados que nunca.
Finalmente Pabro Chagra, experto en temas de la farándula, aseguró que Karol Sevilla sí se está dando una oportunidad en el amor con Diego Monroy de las Águilas del América pues durante el ensayo estaba presente su mamá, quien vio las muestras de cariño entre los jóvenes.
AGENCIAS PALERMO
Liam Payne, ex integrante de One Direction, antes de morir supuestamente fue despedido de Universal Music, la disquera que lo representaba desde 2016 luego de que se separó de Harry Styles, Zayn Malik, Louis Tomlinson y Niall Horan, así lo dio a conocer una fuente cercana a Daily Mail.
La misma persona que reveló tal información al medio extranjero comunicó que su ex pareja, Maya Henry, lo denunció por supuestamente acosarla.
De acuerdo con Page Six, “el segundo álbum de Liam Payne quedó en espera antes de que el sello discográfico (Capitol Records, propiedad de Universal Music) cortara los lazos” con el famoso ex integrante de One Direction.
A la noticia se le sumó que supuestamente el equipo de publicidad de Payne renunció a principios de octubre. Universal Music, tras darse a conocer la muerte de Liam Payn, compartió un mensaje en sus redes sociales en donde le dio el pésame a la familia del cantante. “Estamos devastados por el trágico fallecimiento de Liam Payne. Su legado vivirá a través de su música y los incontables fans que inspiró y que lo adoraron. Enviamos nuestro más sentido pésame a la familia y seres queridos de Liam”, se lee en la publicación de la disquera.
En la publicación de Universal Music que muestra una foto del ex integrante de One Direction fueron desactivados los comentarios debido a que los fans del cantante no estuvieron de acuerdo con su publicación, acusando a la disquera de haber abandonado a Liam Payn.

AGENCIAS ESTADOS UNIDOS
BLACKPINK es uno de los grandes grupos K-Pop y cada una de sus integrantes ha logrado consolidarse de manera individual. Rosé, quien hace poco asistió a la Fashion Week de Milán, ya comenzó con las promociones de su comeback como solista al lado del gran Bruno Mars.
Rosé es una de las grandes promesas pop en el K-Pop, la joven ha mostrado un gran amor por la música a lo largo de su carrera. Hace un par de años debutó con “On the ground”, este 2024 decidió regresar con “Rosie” su próximo álbum, previo a los planes de
BLACKPINK para 2025. Este jueves, Rosé sorprendió a sus fans con el primer sencillo promocional de su disco, nada más y nada menos que al lado de Bruno Mars. El video ya registra más de 18 millones de visitas a menos de 24 horas de su estreno y promete ser uno de los hits de fin de año.
Rosé y Bruno Mars conquistaron con su química a través de “APT.”, su primera y nueva colaboración K-Pop. El cantante participó en la producción y dirección de la canción y el video. El álbum completo se estrenará hasta el 6 de diciembre, pero este sencillo promocional ya conquistó a todos los fans.
Sobre el significado de “APT.”, Rosé compartió que es un juego de bebida coreano para romper el hielo, aunque no se profundiza en cómo se juega, posiblemente se trata de cantar una canción mientras hacen movimientos con sus manos y aparentemente quien pierda debe beber un trago. La idol se sintió insegura al inicio, pues no sabía si era una buena idea lanzar una letra con dicha temática.
Sin embargo, de acuerdo con el comunicado de lanzamiento, Rosé le presentó el juego a su equipo en el estudio de grabación y quedaron encantados, igual que Bruno Mars, fue así que se surgió la colaboración de “APT.”. Sobre la estética del video, rememora mucho a la época noventera del rock y algunas películas, con tonos rosados y chamarras de cuero.
Periodista cerró su ciclo en televisión y compartió un conmovedor mensaje
AGENCIAS
MÉXICO
La noche del jueves 17 de octubre el periodista, Ciro Gómez Leyva cerró su ciclo como titular del noticiero nocturno de la cadena Imagen Televisión. En plena transmisión en vivo el conductor confirmó que este día ya no estará presente en el noticiero poniendo fin a ocho años al frente.
Desde hace unas semanas te informamos que el también conductor de radio dejaría de formar parte del elenco de conductores de Imagen Televisión. Su lugar en el noticiero nocturno será ocupado a partir de este lunes 21 de octubre por el
periodista, Nacho Lozano.
Durante la noche de ayer Ciro Gómez Leyva se tomó unos minutos para confirmar que este jueves 17 de octubre cerraría su ciclo como presentador del noticiero nocturno de Imagen Televisión. El periodista recordó que estuvo al frente del programa durante ocho años. En este sentido, el conductor de radio agradeció el apoyo de la audiencia y recordó algunos de los momentos que marcaron su etapa como presentador de noticias, como la pandemia ocasionada por el coronavirus Covid-19, el atentado que sufrió en diciembre pasado y los señalamientos que recibió desde Palacio Nacional.
AGENCIAS
ESTADOS UNIDOS
La saga de Karate Kid resurge hace algunos años gracias a Cobra Kai una serie que continúa la historia de peleadores como Daniel LaRusso y Jhonny Lawrence quien protagonizaron un increíble encuentro en la primera película, donde además uno de los maestro más icónicos del cine hace su primera aparición como lo es el Maestro Miyagi.
Ahora tras el estreno de la primera tanda de de episodios de la última temporada de Cobra Kai, así como el lanzamiento de la segunda oleada este 15 de noviembre de 2024, Netflix está viviendo el sueño de tener en Karate Kid un número de fanáticos razonables viendo la continuación de una película de 1984.
Por lo que en busca de crear más historia lardera de todos los personajes que tiene la serie, se ha anunciado y mostrado el primer póster de una nueva película que Ralph Macchio y Jackie Chan protagonizarán en el cine.
Pues es la unión oficial de la película original de 1984 con el interno de remake de 2010 donde jackie Chan entrena a Jaden Smith en uno de sus primeros papeles en la industria de Hollywood, algo que ha sorprendido a todos los fanáticos de la película original, pues Ralph Macchio y Jackie Chan estan juntos por primera vez.


La película estará dirigida por Jonathan Entwisie y escrita por Rob Lieber, siendo estrenada un 30 de mayo de 2025, tras los retrasos por el mal recibimiento de la última temporada de Cobra Kai, pues se esperaba su estreno para finales de 2024 algo que al final se moverá para el próximo año.
Reuniendo a la saga original con el remake por primera vez; sin embargo, el showrunner de Cobra Kai habló sobre la especulación de que se uniría este universo con Jackie Chan con el de Ralph Macchio en una película que estará esperando el más aficionado a Cobra kai y Karate Kid.
Jackie Chan volverá como el maestro Han, quien en la película de 2010 entrenó a Dre Parker, siendo una representación del maestro Miyagui quien se robó el corazón de las personas en la primera película, que si bien fue un éxito en taquilla la gente no acompañó a los nuevos personajes esperando ver a los originales de Karate Kid.
AGENCIAS MÉXICO
Lupillo Rivera se convirtió en el centro de atención durante los Premios Billboard a la Música Latina 2024 al asistir con una prenda que no pasó desapercibida. El cantante eligió una playera con la imagen del controvertido rapero Sean ‘Diddy’ Combs, quien actualmente enfrenta un juicio con más de 100 denuncias por presuntos crímenes graves, entre ellos abuso, explotación y más.
Lo que sorprendió aún más a los presentes y a los usuarios en redes sociales fue el detalle de la camiseta: la imagen de Diddy estaba marcada con una gran “X” roja, como un claro símbolo de rechazo hacia el rapero. Este gesto del exparticipante de ‘La casa de los famosos’ de Telemundo no solo llamó la atención en la alfombra roja, sino que desató una ola de comentarios en las redes, donde muchos aplaudieron su valentía para dar visibilidad a este tema.
A través de su cuen-
ta de Instagram, el cantante compartió un video de su participación en la alfombra roja de los premios, en el que aparece luciendo la playera y de fondo su canción ‘Grandes ligas’, colaboración que hizo con Alemán, Santa Fe Klan, B-Real y Snoop Dogg.
Junto al video, escribió: “¿Les gusta mi outfit, raza?”, provocando rápidamente una lluvia de comentarios por parte de sus seguidores.
“OMG eso es tener hue...”, “Ese es mi Lupe”, “Lupillo con sus pensamientos claros y decisivos”, “Sin miedo al éxito”, “Eso es alzar la voz”, “Ya sabemos a quién culpar si te pasara algo, Lupe”, fueron algunos de los comentarios mostrando su apoyo al cantante.

AGENCIAS ESTO
Sergio Pérez protagonizó este viernes un mal comienzo de actividades dentro del Gran Premio de Estados Unidos. Primero, el mexicano no sacó el mayor provecho a la única sesión libre del fin de semana y se colocó en la décima sexta posición. Cuando se pensó que todo podía mejorar en la clasificación de la carrera Sprint, tampoco lo hizo y quedó fuera de los 10 mejores.
Checo Pérez, del equipo Red Bull, arrancará desde la posición 11 para afrontar esta carrera rápida en el trazado de Austin, donde deberá remontar de manera repentina si quiere finalizar entre los ocho primeros lugares que pueden cosechar unidades.
El tapatío al igual que el resto utilizó neumáticos medios en la primera parte de la qualy y dio indicios de mejoría cuando se colocó muy cerca de su vecino de garaje Max Verstappen, no obstante, le sacaron el tiempo al mexicano debido a que excedió los límites de pista.
En una qualy en la que el mar-
AGENCIAS
ESTO
Y aunque Pumas regresó al camino de la victoria, no se confían y futbolistas tienen claro que pese a estar en un buen momento, por la filosofía del club al que representan, no pueden dejar de ser intensos, incluso, José Luis Caicedo recalcó que en Universidad la entrega y la garra no son negociables, y menos cuando juegan en su casa, como es el caso de este domingo
gen de error es más corto, Pérez Mendoza era último de la clasificación con tres minutos por delante. El jalisciense concretó una vuelta competitiva y superó el corte al colocarse en el séptimo escalón con lapso de 1:34.333 minutos. La sorpresa en esta primera etapa fue la eliminación de Oscar Piastri, de McLaren, en tanto que Leclerc, Hamilton y Verstappen comandaron.
¿En qué lugar quedó Sergio Pérez en la clasificación de la Carrera Sprint del Gran Premio de Estados Unidos?
Para el Shootout Q2, “Checo” lo intentó, pero la estrategia en el día que regresó su ingeniero de carrera Hugh Bird, no funcionó. La apuesta del mexicano en arriesgar todo a una vuelta lo dejó sin opciones de ir más allá con su “RB20”, aunado a las irregulares en su rendimiento con los neumáticos.
Pérez realizó su mejor giro en 1:34.244 minutos para situarse en el décimo peldaño, pero ante la falta de otros pilotos por cerrar su vuelta era cuestión de tiempo para quedar eliminado sin opciones de pelear

la “pole position”. El japonés Yuki Tsunoda, de Racing Bulls, quien precisamente sonó para suplir al tapatío en el toro rojo, se encargó de desplazar a “Checo”. Con esa eliminación tempranera en la etapa de clasificación, Sergio Pérez cerró un día para el olvido y el panorama empeoró cuando su compañero Max
que recibirán al Atlético San Luis en el Estadio Olímpico Universitario.
“Pumas es eso, que no se negocia la intensidad, la garra y siento que cada partido salimos a hacer lo mismo independientemente de que algunas veces no se nos dan los resultados, pero igual es esa parte que en Pumas no se negocia la garra y la intensidad, y más ahora que jugamos en casa” dijo en conferencia de prensa.
¿Qué opina José Caicedo sobre Gustavo Lema?
En tanto, el mediocampista fue cuestionado sobre la labor que ha hecho Gustavo Lema al frente del equipo y el hecho de que hasta hace no mucho. La afición auriazul estaba molesta con él, a lo que el colombiano señaló que el timonel felino sabe cómo trabajar y la institución que representa.

Verstappen se adueñó de la posición de privilegio para esta carrera Sprint a celebrarse el sábado.
“Mad Max” llevó el mando en la instancia decisiva y con lapso de 1:32.833 minutos se apoderó del primer peldaño para el Sprint estadunidense, por delante de George Russell (Mercedes), Charles Leclerc (Ferrari) y Lando
“El profe ha sabido a manejar esa presión de la mejor manera, y obvio siempre ha tenido el respaldo de nosotros e independientemente de lo que haya pasado. Creo que los resultados hablan por sí mismos.
Ahora el profe está más tranquilo y sabe también lo que se juega en esa gran institución”, expresó.
Al margen, José Luis Caicedo habló sobre el hecho de que este domingo jugarán ante el Atlético San Luis en el horario del mediodía, el cual ya era tradicional para Pumas, pero que en este torneo tuvieron muy pocos partidos a las 12, e incluso el de este fin de semana es el último de la Fase Regular a esa hora.
“Es un lindo horario la verdad estamos con nuestra gente, independientemente del horario en que juguemos eso es lindo. Porque sentimos el apoyo de nuestra gente y eso (el horario) no nos puede afectar”, indicó.
¿Cuántas tarjetas amarillas tiene Caicedo en el Apertura 2024?
José Luis Caicedo tiene hasta el momento cuatro tarjetas amarillas, por lo que en caso de ser amonestado ante el Atlético San Luis el domingo. Se estaría perdiendo el juego ante Rayados del próximo miércoles, o se perdería el juego siguiente al que sea amonestado. Aun así, el jugador colombiano advirtió que pese a estar condicionado él seguirá jugando igual.
“Sí es complicado jugar con las cuatro amarillas, pero independientemente eso no implica que no deba meter el pie fuerte o hacer una falta. Yo juego partido e independientemente de las cuatro amarillas, creo que no me complico en esa situación”, señaló.
Norris (McLaren), en una variada parrilla de salida que promete emociones. Carlos Sainz, Nico Hulkenberg, Lewis Hamilton, Kevin Magnussen completan los primeros ocho lugares de largada para esta competición sabatina en la que los primeros ocho lugares nada más sumarán puntos para el Campeonato de Pilotos.
AGENCIAS ESTO
Ricardo Contreras vive sus últimas horas al frente de la Federación Mexicana de Boxeo (FMB) ya que este fin de semana se realizará la Asamblea
Anual Ordinaria donde habrá elecciones y el dirigente, quien estuvo 36 años al frente del organismo, no presentó planilla para reelegirse.
Contreras Hernández estuvo nueve ciclos olímpicos “todo termina y el mío ya debió haber terminado hace mucho tiempo, pero mis compañeros siempre insistieron en que me quedara como presidente, pero hoy ya terminó mi ciclo”, comentó el dirigente.
¿Cuántas medallas olímpicas obtuvo el boxeo mexicano con Ricardo Contreras como presidente de la FMB?
Durante su gestión, el boxeo mexicano conquistó tres medallas en los Juegos Olímpicos. La primera fue en Sidney 2000 cuando Christian Bejarano logró el bronce en el peso ligero.
Tuvieron que pasar 16 años para que nuevamente un pugilista tricolor subiera al podio: lo hizo Misael Rodríguez en Río de Janeiro 2016 y fue bronce.
La más reciente presea fue la que conquistó Marco Verde en la justa veraniega que se realizó en París. Verde logró la medalla de plata.
“Voy a entregar una federación fuerte, sólida, unida y trabajando. Además, con resultados como lo fue la medalla olímpica que ganó Marco Verde en París que se logró gracias a un trabajo conjunto entre la Federación, la Asociación de Sinaloa y con sus entrenadores. Esto muestra que el trabajo de la Federación ha sido positivo”, agregó Contreras Hernández. ¿Quién suplirá a Ricardo Conteras como presidente de la FMB?
El pasado 4 de octubre, se cerró el registro de planillas y asuntos generales para la realización de la Asamblea Anual Ordinaria que se llevará a cabo este sábado en las instalaciones del Comité Olímpico Mexicano (COM). Sólo se presentó un equipo que es encabezado por Óscar Contreras, quien actualmente es secretario general de la FMB.
Contreras tiene 15 años en la FMB donde ha desempeñado diversas actividades lo que, aseguró, le permitirá manejar de buena manera el organismo.
AGENCIAS ESTO
América no vive su mejor momentoenlatemporada.Después de conseguir el Bicampeonato, las Águilas han vivido un Apertura 2024 de altibajos y André Jardine lo sabe. Por este motivo, el técnico americanista coincidió con el dueño del equipo, Emilio Azcarraga, quien a media semana declaró que en Coapa han “quedado a deber”.
¿André Jardine reconoce que el América ha quedado a deber en el Apertura 2024?
“Cien por ciento (de acuerdo con las palabras de Azcarraga), los títulos de un equipo te generan expectativa natural de todos, de la prensa, de la afición, del dueño, de todos nosotros mismos, las expectativas aquí son muy altas. Nosotros mismos trabajamos para superar esto y bien”, dijo el estratega brasileño en conferencia de prensa.
Con el partido ante Santos Laguna en puerta, André Jardine puso el pecho a las balas y fue el primero en reconocer que no han
Jordan
AGENCIAS
ESTO
cumplido con las expectativas que tiene todo el entorno azulcrema. El primer paso para revertir la situación es comenzar a trabajar en las desatenciones que han tenido dentro del campo para poder volver al nivel que los llevó a conquistar el Apertura 2023 y el Clausura 2024 de forma continua.
“Lo más importante es tener la claridad y tranquilidad para analizar el porqué de las cosas y no desesperarnos, no elegir culpables o crear problemas donde no se tiene. Al mismo tiempo hay que ser frontal con los problemas que tenemos, entenderlos para intentar superarlos lo más rápido posible, para reencontrárnoslas en el nivel que queremos, que sabemos que podemos tener y atender a la expectativa de todos, no solamente de nuestro patrón, de nuestra afición y de ustedes (la prensa) que quieren ver siempre al América bien”, agregó.
¿Cuántas victorias suma América en los últimos tres partidos de local?
En los últimos tres encuen-

tros que América ha disputado en el torneo local no han podido cosechar una victoria, situación que tiene con cierto grado de inconformidad a la hinchada, pero, sobre todo, al propio plantel. “Tal vez el cliente más importante somos nosotros mismos que nos vemos vencedores, nos
Aunque la campaña regular 2024-2025 de la NBA todavía ni empieza, en el equipo de Washington Wizards ansían cumplir con su visita a la Ciudad de México para afrontar el partido del próximo 2 de noviembre ante Miami Heat.
El head coach Brian Keefe y el guardia Jordan Poole expresaron su entusiasmo por disfrutar de la atmósfera que se prevé exista en la Arena Ciudad de México en un encuentro más de temporada regular que se desarrollará en la capital del país.
Jordan Poole tiene ganas de jugar en México Jordan Poole, quien es una de las figuras de Wizards, reconoció que por primera vez visitará México y que mejor manera que hacerlo en un enfrentamiento ante una franquicia de mucho prestigio en un escenario en el que vislumbra un magnífico espectáculo.
“Estoy extremadamente emocionado de poder ir a jugar otro partido internacional durante la temporada regular este año. La Ciudad de México

es increíble. Nunca he estado antes. También jugaremos contra Miami Heat, que es una franquicia bastante prestigiosa, así que poder jugar el juego que amamos en un escenario más grande, un escenario diferente, siempre es una bendición”, expresó.
Jordan asegura que jugar en un estadio lleno siempre es divertido Quien fuera campeón de la NBA en 2022 con Golden State Warriors restó importancia al hecho de que el Calor de Miami pueda tener más arropo en el recinto de la alcaldía Azcapotzalco, lo único que desea es gozar de esta nueva experiencia.
“Estoy emocionado. Escuché que se agotaron las entradas, así que poder jugar en un estadio lleno siempre es divertido. Siento que habrá mucha energía, mucha energía positiva en torno al evento en general. Creo que la ciudad en general tendrá mucha energía positiva”, indicó Poole en conferencia de prensa virtual.
Por su lado, Brian Keefe adelantó que han tenido una fenomenal preparación para el comienzo de la campaña y por supuesto para el encuentro programado en la capital mexicana como parte de la globalización de la NBA.
“Hemos tenido un buen campo de entrenamiento hasta ahora, creando hábitos. Tenemos muchas ganas de estar en la Ciudad de México para ser parte de los Juegos Globales. Tener la oportunidad de que conozcan mejor a nuestro equipo en todo el mundo. Especialmente en la Ciudad de México, que es un gran lugar para jugar al baloncesto”, indicó el manejador de Wizards. De igual manera el head coach aceptó que será su primera experiencia de un partido de NBA en México, al mismo tiempo que se dijo encantado de aprovechar la visita para conocer y adentrarse más a la cultura mexicana, sobre todo a las festividades del Día de Muertos.
vemos todos como profesionales y que estamos para cosas grandes. Estamos trabajando inquietos e incomodos con este escenario, estamos moviendo todo para tan pronto colocarnos en la situación que queremos estar”. Asimismo, lamentó que a inicios de la campaña hayan dejado
Directiva de Chivas manda
“pedrada” contra Fernando Gago
AGENCIAS ESTO
En Chivas se tomarán el tiempo suficiente para decidir de la mejor manera el futuro en el banquillo rojiblanco, al menos así lo dio a entender el director del Comité Técnico Deportivo en el club, Juan Carlos Martínez Castrejo en charla con los canales institucionales del club, publicado en redes sociales.
Además de hacer oficial la permanencia de Arturo Ortega, mencionó el cambio en la estructura de ascender a Pepe Meléndez de la Sub-23 al Tapatío. Finalmente, no perdió oportunidad de lanzarle una indirecta a Fernando Gago tras su salida del club.
“Estamos los que queremos estar en Chivas y estamos muy contentos de que todos estemos muy juntos aquí. Cuando el entrenador anterior se va, ha sido muy fácil la respuesta. Hay un entrenador que va a estar en el primer equipo que es Arturo Ortega con su cuerpo técnico de Tapatío. Subimos a Pepe Melendez a Tapatío
ir unidades que hoy les ayudarían a estar en una posición menos adversa de cara al cierre de la fase regular. Con apenas 14 unidades después de 11 fechas, América tiene muy poco margen de error si desea entrar a la Liguilla de forma directa, Jardine es consciente de ello.
para que se haga cargo del equipo”. El plantel de Chivas está herido por la salida de Fernando Gago Juan Carlos también mencionó que el estado anímico del equipo está dañado. En el grupo tienen el dolor de no haber recibido honestidad por parte de su anterior estratega respecto a su situación y el ofrecimiento de Boca Juniors.
“No hay que mentir nunca y decir lo sucedido. Evidentemente el equipo en un primer momento está herido por esa falta de confianza y compromiso y ahora estamos en la fase de reconocimiento de la situación, que tenemos seis partidos por delante muy importantes para la entidad y el grupo. De alguna forma los objetivos que están marcados desde el primer momento que es pasar a esa liguilla de forma directa como primer objetivo y después ir a competir por el título, por ser campeones de este torneo”.


AGENCIAS MÉXICO
Lluvias y bajas temperaturas se extendieron en varios estados de la República, dejando al menos tres muertos y afectaciones en vialidades.
En Nuevo León, las fuertes precipitaciones dejaron encharcamientos, autos varados y tres personas sin vida que fueron arrastradas por la corriente en los municipios de Monterrey y Guadalupe.
Protección Civil del estado
Senado da a conocer
AGENCIAS
MÉXICO
informó que debido a la entrada del frente frío número 4 en la región se presentan lluvias de moderadas a fuertes en distintos puntos del área metropolitana.
En la avenida Lincoln y Gonzalitos, en la colonia Mitras Centro, se atendió a personas cuyos vehículos quedaron varados.
Además, se realizó el rescate de dos cuerpos, en dos puntos diferentes. El primer caso se registró en la avenida Lincoln y Jaumave, y el segundo en Policasta, en la colonia
Las comisiones unidas de Derechos Humanos y Justicia del Senado, dieron a conocer 48 finalistas para elegir a quien presidirá la CNDH, entre los que destacan Rosario Piedra Ibarra, quien busca su reelección por otros cinco años y Nashieli Ramírez Hernández, actual presidenta de la Comisión de Derechos Humanos de la Ciudad de México.
También se encuentran Tania Ramírez Hernández, directora de la Red por los Derechos de la Infancia en México (Redim), y Jesús González Schmal, exdiputado y excandidato a alcalde por Morena.
Durante la reunión de dichas comisio-
Valle de Infonavit. Ambas víctimas eran personas de la tercera edad.
En Guadalupe se recibió el reporte de una persona tirada en la vía pública y al llegar confirmaron su deceso.
Autoridades contabilizaron 111 inundaciones en domicilios, 159 vehículos varados, siete árboles caídos, 21 cortocircuitos y tres cables caídos.
Ante el mal tiempo, el gobierno estatal emitió una serie de recomendaciones a la población como evitar cruzar por ríos y arroyos.
AGENCIAS MÉXICO
El Aeropuerto Internacional de la Ciudad de México (AICM) ha transportado 2 millones de pasajeros menos este año debido a la reducción de operaciones para vuelos nacionales, que busca aliviar su saturación y que las aerolíneas utilicen el Aeropuerto Internacional Felipe Ángeles (AIFA), que ganó 2.6 millones de usuarios.
Sin embargo, el contralmirante José Ramón Rivera Parga, director general del aeropuerto capitalino, dijo que está dispuesto a incrementar el número de operaciones por hora en horarios saturados, si la Agencia Federal de Aviación Civil (AFAC) así lo ordena.
“Somos respetuosos de la autoridad y esa cantidad de horarios fue definida por la autoridad correspondiente. En caso de que se haga una reevaluación y considere la autoridad incrementar la capacidad de las operaciones por hora estamos más que listos”, comentó Rivera Parga en una entrevista el mes pasado.
El aeropuerto Benito Juárez movió 34 millones de viajeros de enero a septiembre de este año, 2 millones menos que en el mismo periodo de 2023 y 3.3 millones por debajo de igual lapso de 2019, cuando alcanzó un máximo histórico, de acuerdo con los reportes del propio AICM.


nes, se acordó que los finalistas comparecerán del jueves 24 de octubre y hasta el sábado 26 de octubre.
Un total de 18 aspirantes no cumplieron con los requisitos de idoneidad, en su mayoría por no certificar los documentos
que presentaron, por lo que fueron eliminados.
Rosario Piedra Ibarra, quien fue electa en medio de polémica como presidenta de la CNDH y quien ha sido cuestionada por su militancia y defensa de funcionarios
de Morena, busca ser reelecta en el cargo. Se prevé que comparezca el viernes 25 de octubre, a las 18:30 horas.
Las comisiones unidas de Derechos Humanos y Justicia, avalaron por unanimidad este viernes la elegibilidad de estos aspirantes, que cumplieron con los requisitos establecidos en la convocatoria.
La presidenta de la Comisión de Derechos Humanos, Reyna Celeste Ascencio, destacó la trascendencia para el país de este proceso de selección de quien estará al frente de la CNDH los próximos cinco años.
Reiteró que “48 personas han cumplido con los requisitos de la convocatoria y son elegibles a la titularidad de la Comisión Nacional de los Derechos Humanos para el periodo 2024-2029”.
Informó que se inscribieron un total de 66 aspirantes -42 hombres y 24 mujeres-, pero 18 no cumplieron con los requisitos por lo que fueron eliminados.

AGENCIAS MÉXICO
El ciclón tropical Quince se formó hoy 18 de octubre de 2024 en el occidente del Mar Caribe, alertó la Comisión Nacional del Agua.
Se prevé que el ciclón tropical Quince se convierta la tarde del sábado 19 de octubre de 2024 en la tormenta tropical ‘Nadine’ entre Belice y México, la tarde de este viernes se localiza a 315 km al este-sureste de Puerto Costa Maya, Quintana
Roo, y a 340 km al este de Ciudad de Belice, Belice, con vientos máximos sostenidos de 55 km/h, rachas de 75 km/h y desplazamiento hacia el oeste-noroeste a 11 km/h. Las bandas nubosas del ciclón tropical Quince, en inte-

AGENCIAS MÉXICO
El gobierno de la presidenta Claudia Sheinbaum Pardo denunciará ante el Consejo de la Judicatura Federal (CJF) a la jueza que ayer ordenó eliminar la publicación del decreto de la reforma al Poder Judicial del Diario Oficial de la Federación (DOF).
La postura de la presidenta Shienbaum fue es respuesta a la resolución que ayer emitió la jueza Décimo Noveno de Distrito en Veracruz, Nancy Juárez Salas, quien ordenó a la mandataria, así como al director del DOF, bajar el decreto de reforma al Poder Judicial, para lo cual dio un plazo de 24 horas.
En su resolución, la jueza explica que el ordenamiento responde a la suspensión provisional del pasado 15 de septiembre, en la que se había
ordenado lo mismo al entonces presidente Andrés Manuel López Obrador, por lo que advirtió que de no cumplirse se daría vista al Ministerio Público de la Federación. En conferencia desde Palacio Nacional, Ernestina Godoy Ramos, consejera jurídica de la Presidencia, explicó los argumentos jurídicos por los que dicho ordenamiento judicial resultaba “inverosímil” y “totalmente improcedente”. En ese sentido, la consejera jurídica sostuvo que los juzgadores carecen de facultades para someter a revisión jurisdiccional una reforma constitucional, por lo que una resolución como la de la jueza Juárez Salas implica una usurpación de funciones y un “clarísimo” conflicto de interés. Godoy Ramos explicó que a petición de la presidenta Claudia Sheinbaum se presentaría una denuncia ante el Consejo de la Judicatura para revisar la actuación de los jueces de distrito que están “contraviniendo la Constitución”, reiteró.
AGENCIAS MÉXICO
racción con el frente frío 4, provocará lluvias torrenciales, de 150 a 250 mm, en Campeche, Yucatán y Quintana Roo.
A su vez, se prevén rachas de viento de 60 a 80 km/h, oleaje de 2 a 4 metros de altura y posible formación de
trombas marinas en las costas de Campeche, Yucatán y Quintana Roo. Las autoridades mexicanas establecieron zona de vigilancia por efectos de tormenta tropical desde Chetumal hasta Quintana Roo.
La coordinadora del PAN en la Cámara de Diputados, Noemí Berenice Luna, advirtió que México se dirige a una crisis de constitucionalidad por las leyes en diversos temas aprobadas “sobre las rodillas”.
Luna Ayala expresó que, en sólo un mes se han reformado más de 10 de los 136 artículos que tiene la Carta Magna, lo que representa un cambio de régimen con las libertades de los mexicanos, acotadas. “Es que no pareciera que están legislando sobre las rodillas ¡Están legislando sobre las rodillas! Yo he oído a legisladores de Morena decir ¿Qué estamos haciendo? El problema es que termina votando
como se los indican”, expresó. La también secretaria general de Acción Nacional, denunció que se ha ejecutado el oficialismo en el Congreso de la Unión, en su afán de conducir a México hacia una tiranía, por lo que celebró el anuncio del INE de pausar la organización de la elección de juzgadores en espera de los resolutivos judiciales correspondientes. Sobre la crisis constitucional, agregó que, ocurre por la vulnerabilidad de la Constitución Política y el desempeño de sus funciones centrales, porque el gobierno instruye a sus legisladores -conformados en una mayoría artificial- para seguir impulsando leyes contrarias al espíritu de la Carta magna, misma que se está quedando endeble, sin poder responder claramente al régimen dictatorial al que nos llevan.

El Departamento de Salud de Florida ha emitido una advertencia sobre el incremento de infecciones causadas por la bacteria Vibrio vulnificus, comúnmente conocida como “bacteria carnívora”, tras el paso de los recientes huracanes Helene y Milton.
Esta bacteria, que habita en aguas marinas cálidas, ha generado preocupación en los condados costeros de Florida debido a su peligrosidad y los efectos devastadores que puede tener en personas vulnerables.
De acuerdo con Fox Weather, el número de infecciones ha aumen-
tado considerablemente en 2024, con 70 casos y 11 muertes registradas hasta la fecha, lo que se asemeja a las cifras observadas tras el huracán Ian en 2022. Los condados más afectados por esta ola de infecciones incluyen Citrus, Hernando, Hillsborough, Lee, Pasco, Pinellas y Sarasota, según las autoridades de salud.
La bacteria Vibrio vulnificus se encuentra en aguas cálidas y salobres, y los ciclones tropicales recientes han incrementado el riesgo de exposición al empujar aguas contaminadas hacia áreas pobladas.
Las personas pueden infectarse al consumir mariscos contaminados o al exponer heridas abiertas al
agua. Aunque las infecciones por Vibrio son poco frecuentes, representan un grave peligro para personas con sistemas inmunológicos comprometidos o con enfermedades hepáticas.
El Departamento de Salud de Florida ha advertido que las infecciones pueden ser letales si la bacteria entra en el torrente sanguíneo, provocando fiebre, shock séptico y severas lesiones cutáneas.
Para reducir el riesgo, las autoridades recomiendan evitar el consumo de mariscos crudos y no exponer heridas a aguas marinas o estancadas, especialmente en las zonas afectadas por los huracanes.
AGENCIAS
ARGENTINA
La ministra de Seguridad de Argentina, Patricia Bullrich, presentó este jueves el programa “Manos a la Obra” en el Complejo Penitenciario de Ezeiza. Este nuevo plan, que será implementado a nivel nacional por el Servicio Penitenciario Federal (SPF), busca garantizar que todos los internos trabajen mientras cumplen sus condenas. Bullrich destacó la importancia de este programa al afirmar que “este lanzamiento es un punto muy importante
en el camino de las transformaciones y la reestructuración del SPF, y de la relación que tienen las personas privadas de su libertad con la deuda que tienen con la sociedad”. También subrayó que “las cárceles tienen que ser sanas y limpias, no para castigos sino para la reinserción” y enfatizó que “las personas privadas de su libertad deben hacerse cargo de mantener las instalaciones penitenciarias y de pagar con su trabajo aquello por lo que hoy están detenidas”.
El programa inició con una prueba piloto en el Complejo 4 de mujeres de Ezeiza, donde el personal penitencia-
AGENCIAS
CUBA
El sistema eléctrico de Cuba sufrió un colapso total este viernes, dejando a toda la isla sin suministro eléctrico. El Ministerio de Energía y Minas (Minem) informó en redes sociales que “a las 11:07 de esta mañana, debido a las condiciones en que está operando el Sistema Eléctrico Nacional (SEN), se produjo su desconexión total”. El ministerio añadió que las autoridades ya están trabajando en el proceso de restablecimiento. El origen del apagón masivo se atribuye a una avería en la central termoeléctrica de Guiteras, una de las plantas más importantes del país. La falla obligó a los técnicos a desconectar la planta del sistema, lo que agravó la situación energética. La Unión Eléctrica (UNE) había informado previamente que la central necesitaba mantenimiento tras haber estado operando durante todo el verano y superar las cuatro décadas de funcionamiento.
El colapso era inminente esta semana. Ante la “emergencia energética” que enfrenta Cuba, el gobierno decidió paralizar todas las actividades laborales estatales que no sean indispensables, informó el jueves el primer ministro, Manuel Marrero.
El primer ministro afirmó que la disposición es para priorizar el servicio a los hogares. Por su parte, el presidente Miguel Díaz-Canel dijo en la red social X que la isla enfrenta una “emergencia energética” por los problemas para adquirir combustible en el exterior para alimentar su sistema de energía.


rio organizó tareas de mantenimiento que ahora se replicarán en todo el país. Además, se implementarán sistemas biométricos para controlar horarios y clasificar a los internos para una asignación más eficiente de tareas.
Bullrich anunció que presentará un proyecto para modificar la ley de ejecu-
ción de la pena privativa de la libertad, asegurando que “el trabajo es trabajo y al que no trabaje no le vamos a pagar un salario”. El subsecretario de Asuntos Penitenciarios, Julián Curi, destacó que en los últimos diez meses han enfrentado “620 hábeas corpus y ganamos todos”, y mencionó que se está trabajando en un proyecto para modificar la ley orgánica del SPF, así como en la mejora de los pliegos para licitaciones de comida. Finalmente, el director nacional del SPF, Fernando Martínez, reafirmó que la implementación de este programa refleja el compromiso de la fuerza de seguridad por cambiar “las cosas que están mal desde hace mucho tiempo”.



El desarrollo psicomotor de un bebé prematuro puede presentar un ritmo más lento y desafíos únicos debido a la inmadurez con la que nace y es una situación que muchas madres de bebés prematuros enfrentan. El retraso psicomotor se refiere a una demora o lentitud en la secuencia normal de adquisición de los hitos del desarrollo. En el caso de bebés prematuros, este retraso se manifiesta como un desarrollo más lento y con una calidad de movimiento diferente.
La buena noticia es que la mayoría de los bebés prematuros logrará un desarrollo psicomotor adecuado, aunque a un ritmo más lento que los bebés nacidos a término. Al principio, es común que tengan movimientos poco coordinados, y sus extremidades pueden pasar de rígidas a flácidas y viceversa. Esto es una parte normal de su proceso de desarrollo y no debe generar alarma.
Un aspecto interesante, es que, en muchos casos, los sentidos de los bebés prematuros, como el gusto, el tacto y el olfato, se desarrollan más rápidamente que su coordinación muscular. Esto significa que pueden ser muy receptivos a los estímulos del entorno, incluso si su movimiento es menos preciso.
La importancia de la estimulación temprana
La estimulación temprana se convierte en una herramienta valiosa para apoyar el desarrollo psicomotor de tu bebé prematuro. Los ejercicios diseñados por especialistas en desarrollo infantil pueden ayudar a fortalecer la coordinación motriz y estimular el desarrollo cognitivo.
Es fundamental recordar que, al evaluar el desarrollo de tu bebé prematuro, debes usar la edad corregida ya que proporciona una imagen más precisa de su progreso y te permite establecer expectativas realistas.


A medida que sigues el camino del desarrollo psicomotor de tu bebé prematuro, ten en cuenta algunas pautas que indican que se está desarrollando adecuadamente. Estas pautas deben consi-
derar la edad corregida. Algunos ejercicios para fortalecer los músculos que puedes usar con tu bebé son los siguientes: Tummy time: coloca a tu bebé boca
abajo sobre una manta en el suelo. Esto fortalecerá los músculos del cuello, los hombros y la espalda.
Masajes y estiramientos suaves: realiza suaves masajes en las piernas, brazos y espalda de tu hijo. También puedes ayudar a estirar sus extremidades suavemente.
Juegos de gateo y arrastre son una buena opción para su desarrollo y algunas recomendaciones son las siguientes:
Túnel de gateo: coloca cojines o mantas para generar un túnel bajo el cual tu hijo pueda gatear y arrastrarse. Esto fortalecerá los músculos de sus brazos, piernas y core.
Circuitos de obstáculos: crea un circuito de obstáculos con almohadas, cojines, cajas y juguetes. Esto estimulará su motricidad y coordinación mientras se desplaza por el circuito.
La estimulación del equilibrio y la coordinación son fundamentales para un buen desarrollo y algunos ejercicios son:
Juegos de equilibrio: haz que tu hijo camine sobre líneas dibujadas en el suelo o coloca cojines en el suelo para que los atraviese sin caerse.
Juego de lanzar y atrapar: lanza una pelota suave y grande hacia tu hijo y anímalo a atraparla. Esto ayudará a desarrollar su coordinación mano-ojo.
El uso de juguetes y elementos para fomentar el movimiento permite un desarrollo cognitivo adecuado para tu bebé y la manera que puedes lograrlo es mediante:
Triciclo o bicicleta sin pedales: proporciona a tu hijo un triciclo o una bicicleta sin pedales para que practique el equilibrio y el movimiento de las piernas.
Pelotas de diferentes tamaños: invita a tu hijo a rodar, patear y lanzar pelotas de diferentes tamaños. Esto promoverá su coordinación motora y su habilidad para agarrar y lanzar objetos



REDACCIÓN
COSCOMATEPEC
Tres jóvenes fueron atacados a balazos afuera del recinto ferial, justo en la plaza del Chayote.
Una de las víctimas perdió la vida en el lugar, mientras que las otras dos fueron atendidas por paramédicos locales, quienes las trasladaron a un hospital de
Córdoba.
De acuerdo a los informes recabados por Diario El Mundo, los hechos ocurrieron alrededor de las 20:20 horas, cuando varios jóvenes en un vehículo, eran perseguidos por sujetos armados.
Según los testimonios, las víctimas fueron alcanzadas afuera de la plaza y dos de ellas lograron salir del vehículo, pero fueron heridas por las balas, mientras

La poca visibilidad a causa de las fuerte lluvias registradas la mañana de este jueves, causaron que al menos tres vehículos quedaran atrapados en socavones que se formaron por fracturas en el pavimento.
Uno de los casos ocurrió minutos antes se las 11 de la mañana, en el socavón formado en la esqui-
que el conductor recibió varios impactos.
En el lugar quedaron tendidos tres jóvenes, mientras que los asistentes se refugiaron en varios locales, hasta que llegaron los elementos de la Policía Municipal.
La zona fue resguardada por los oficiales, quienes pidieron ayuda a los paramédicos locales, los cuales confirmaron la muerte de un joven que

na de Miguel Ángel de Quevedo y Francisco Téllez de la colonia
Puerto México, lugar donde hace casi un mes cayó una camioneta BMW.
Esta vez fue un automóvil marca Chevrolet, tipo Aveo, habilitado como taxi de este puerto, marcado con el número económico 2642, con placas A-825-XGD del servicio de transporte público local.
La unidad transitaba de poniente a oriente sobre Quevedo y su conductor no pudo ver, por lo que cayó en la peligrosa trampa que ya lleva varios meses en ese sitio.
Con la ayuda de una camioneta
Jeep, lograron sacar la unidad que sufrió daños en la suspensión.
Los otros casos fueron en la carretera Antigua a Mianatitlán casi esquina con Hilario C. Salas en la colonia 5 de Febrero, ahí a dos autos particulares se les poncharon las llantas delanteras del lado izquierdo, por lo que sus propietarios tuvieron que usar la de refacción.
El primero fue un automóvil Ford, tipo Figo, color rojo con placas YCP- 312- B, mientras que el segundo fue un automóvil marca Nissan, tipo Versa, color blanco con placas YTC-437-A.
iba al volante, mientras que a los otros dos los trasladaron de emergencia a un hospital. Hasta el momento, las autoridades no cuentan con una línea de investigación respecto al atentado, mientras que el cuerpo fue trasladado a las instalaciones del Servicio Médico Forense (Semefo), en Huatusco, donde podría ser identificado en las próximas horas.


Sin vida y en el interior de su recámara, fue localizado un masculino
REDACCIÓN
CÓRDOBA, VER.
Sin vida y en el interior de su recámara, fue localizado un masculino de 30 años, cuando familiares arribaron a buscarlo en su vivienda asentada en la avenida 27, entre calles 21 y 23 de la colonia Aguillón Guzmán. Fue la mañana de este viernes 18 de octubre que se reportó el hallazgo de una persona en estado crítico, arribando paramédicos de la Cruz Roja, quienes solo confirmaron el deceso tras pre -
suntamente atentar contra su vida, logrando cumplir el objetivo, arrastrado por supuestos problemas amorosos, versión que se especuló al momento del hallazgo. Elementos de la Policía Municipal instalaron la “Cadena de Custodia”, como lo marcan los protocolos para esperar el arribo de las autoridades ministeriales y de la Fiscalía General del Estado, así como peritos en criminalística para hacer el levantamiento de indicios e integrar la carpeta de investigación en torno a la muerte

del masculino del que hasta ahora no se han confirmado las causas de lo ocurrido. El ahora occiso fue identificado como Juan Manuel “N”, de 30 años, con domicilio en la colonia Aguillón Guzmán de esta ciudad de Córdoba, cuyo cuerpo fue trasladado posteriormente al anfiteatro ubicado en el Ejido San Miguelito, donde se le realizaría la necropsia de rigor para confirmar las causas del deceso y posteriormente hacer la entrega a los familiares para darle sepultura.
El regidor noveno del Ayuntamiento de Córdoba fue detenido por elementos de la Policía Ministerial de la Fiscalía General del Estado, como pro-
Joven realizaba trámites en banco BBVA cuando bala perdida impacta en su rostro
REDACCIÓN
BOCA DEL RÍO
Ladrones y el escolta de un cuentahabiente al que pretendían asaltar a las afueras de una sucursal bancaria del fraccionamiento La Petrolera en Boca del Río, generaron la activación del Código Rojo en la conurbación.
Un intenso despliegue por parte de las distintas fuerzas del orden público de los tres niveles de gobierno tuvo lugar la tarde de este viernes tras una balacera, en la que extraoficialmente un maleante resultó herido.
A decir de testigos en las inmediaciones del banco BBVA del bulevar Adolfo Ruiz Cortines, al menos un par de sujetos armados, increparon al cuentahabiente que recién había retirado una fuerte suma de dinero.
No obstante, no se percataron de que el agraviado iba acompañado de un escolta que estaba muy cerca de él, y quien, al percatarse del peligro, de inmediato sacó
su arma para repeler a los delincuentes.
Fue así que se desató el intercambio de disparos y los presentes reportaron que accionaron sus armas unas 15 veces, mientras ellos buscaban donde refugiarse para evitar salir heridos.
Uno de estos sujetos fue alcanzado por una bala, pero junto a su cómplice, lograron darse a la fuga aparentemente en un vehículo que ya los esperaba, mientras los testigos pidieron apoyo mediante el 911.
Elementos de la policía municipal de Boca del Río, policía estatal, ejército mexicano, y la Secretaría de Marina llegaron hasta dicho sitio para tomar conocimiento de lo ocurrido e iniciar la búsqueda de los responsables.
Pese a los distintos puntos de revisión colocados en diversas calles de la zona conurbada, no fue posible dar con el paradero de los ladrones, mientras que la Fiscalía General del Estado ya investiga estos hechos.

bable responsable del delito de violación agravada.
A través de un comunicado oficial, la dependencia de procuración de justicia indicó que se cumplimentó una orden de aprehensión contra Eduardo Edward “N”.
El regidor en funciones de Córdoba se mantenía como independiente al interior del
Cabildo de la Ciudad de los 30 Caballeros.
“Respetando sus derechos humanos será presentado en próxima audiencia inicial ante el juez dice proceso y procedimientos penal oral para que defina su situación jurídica, dentro del proceso penal 680/2024”, dice el documento.
REDACCIÓN
CUITLÁHUAC
Dos supuestos roba tráileres fueron detenidos tras sostener un enfrentamiento contra agentes de la Guardia Nacional, en la autopista Córdoba-Veracruz, a la altura de la caseta de cobro de Cuitláhuac.
El hecho provocó el cierre momentáneo de la circulación y los sujetos quedaron a disposición de las autoridades ministeriales.
Los hechos ocurrieron alrededor de las 15:30 horas, cuando varios traileros reportaron por la banda de radio civil, que en la autopista, muy cerca de la caseta se encontraban dos sujetos armados que aparentemente intentaron asaltar a un camionero.
El informe llegó hasta
las autoridades, siendo elementos de la Guardia Nacional quienes acudieron al sitio, y a la altura del kilómetro 13, se encontraron con dos sujetos, quienes al verlos intentaron escapar mientras le disparaban a los policías.
Los elementos repelieron la agresión, y justo en la caseta de cobro lograron detener a los dos sujetos, quienes portaban dos armas de fuego y varios teléfonos celulares.
Los presuntos roba tráileres fueron trasladados a las instalaciones de la Unidad Integral de Procuración de Justicia, mientras que las armas y el vehículo en el que operaban, quedaron a disposición de las autoridades ministeriales, mientras se llevan a cabo las investigaciones complementarias.


REDACCIÓN COATZINTLA, VER
Efectivos de la Secretaría de Seguridad Pública (SSP), a través de Policía Estatal aprehendieron a seis personas por delitos contra las instituciones, portación ilegal de armas de fuego y delitos contra la salud, considerados generadores de violencia en Poza Rica y la zona norte.
Fuerzas del orden realizaban recorridos preventivos en
el libramiento Bicentenario de Coatzintla, ahí detectaron a seis personas a bordo de un vehículo un vehículo Chevrolet Beat, sin placas y una motocicleta Yamaha, placas 51YMP9.
Los tripulantes viajaban a exceso de velocidad, por ello les marcaron el alto, haciendo caso omiso a la indicación. En ese momento realizaron disparos con arma de fuego, sin lograr lesionar a nadie.
Acto seguido, fueron aprehendidos Ramón “N”, Mauri
Uriel “N”, Edgar “N”, Pedro Yeudiel “N”, Marco Polo “N” y Cesar Eduardo “N” y les aseguraron dos armas de fuego largas y una corta, cargadores, cartuchos útiles, seis armas blancas, chaleco y placa balística, aros aprehensores y un total de 405 dosis de una sustancia granulada parecida a la droga conocida como “cristal”.
Los seis detenidos quedaron a disposición de la autoridad correspondiente, para los trámites de ley.
Fue vinculado a proceso por maltrato animal Erubey N quien lanzó en julio pasado a un gato por los aires en la colonia Adolfo López Mateos de Coatzacoalcos.
El joven que presuntamente cometió el delito de maltrato animal al tirar a un felino, fue vinculado a proceso por un juez en turno, luego de que la Fiscalía General del Estado (FGE), a través de la Fiscalía Especializada en Delitos Ambientales y Contra los Animales le imputó el delito de actos de maltrato o crueldad en contra de los animales, en

agravio del felino, y en agravio y peligro de la seguridad colectiva. El hecho ocurrió en la cancha de fútbol ubicada en la calle Ferrocarril de la

colonia López Mateos y quedó registrado en un video que rápidamente se hizo viral y que sirvió de prueba para que la Fiscalía Especializada le imputara el
delito.
El juez de control ratificó la medida cautelar de firma periódica de manera semanal y estableció tres meses para la investigación complementaria, dentro del proceso penal 670/2024 que se instruye en contra de Erubey N por maltrato animal, por lo que llevará su proceso en libertad.
Aunque Erubey se disculpó por haber cometido el acto de crueldad, autoridades ministeriales dieron seguimiento al caso.
En ese momento Erubey convivía con otros jóvenes y aparentemente estaban bajo los influjos del alcohol.
Aunque la dueña del gato no presentó una denuncia, la fiscalía especializada realizó las diligencias correspondientes para llevarlo ante un juez.
En los entornos laborales se ve una mayor tasa de incidencia del síndrome de burnout, con fatiga crónica e insomnio, entre otros, porque no se permite que haya un tiempo adecuado de descanso y recuperación.
REDACCIÓN
CIUDAD DE MÉXICO
Los dos principales trastornos de salud mental que afectan a la población de México y el mundo son el depresivo y de ansiedad. Según cifras de la Organización Mundial de la Salud (OMS), alrededor de 280 millones de personas sufren depresión alrededor del planeta y en nuestro país, de acuerdo con el Instituto Nacional de Estadística y Geografía (INEGI), aproximadamente 35 millones han experimentado algún episodio depresivo. En tanto, los trastornos de ansiedad afectaron a 301 millones de personas (2019) según el mismo organismo internacional. En tanto, la primera Encuesta Nacional de Bienestar Autorreportado (2021) del INEGI reporta que el 19.3 % de la población adulta tiene síntomas de ansiedad severa, mientras otro 31.3 % revela ansiedad mínima o en algún grado.
Diego Coronel Manzo, del Departamento de Psiquiatría y Salud Mental de la Facultad de Medicina (FM) de la UNAM, explica que al igual que otros males mentales graves, como la esquizofrenia o los trastornos bipolar u obsesivo compulsivo, que tienen prevalencia menor, los antes mencionados pueden afectar la funcionalidad del individuo en diferentes esferas; por ejemplo, en los ámbitos aca-
démico, escolar o laboral, incluso ser motivo de discapacidad psicosocial y de merma de las relaciones interpersonales.
El responsable del Programa de Salud Mental de esa entidad académica afirma que la población adolescente y adulta joven es la más vulnerable a presentar problemas de salud mental. Por ello, deben intensificarse los esfuerzos para promover servicios accesibles de atención y prevención oportuna en la materia.
Menciona además que no es lo mismo atenderlos cuando se identifican de manera temprana, a hacerlo una vez que han pasado algunos años y la condición se ha cronificado y el proceso de recuperación es lento.
Con motivo del Día Mundial de la Salud Mental, que se celebra hoy 10 de octubre, el especialista precisa que la prevalencia de las enfermedades de la mente se incrementa conforme el individuo se enfrenta a factores psicosociales asociados al estrés incluyendo pérdidas, ingreso o despido de un trabajo, divorcio, etcétera.
Pero también hay de tipo biológicos que pueden predisponer, en diferentes edades a mujeres y hombres, a presentar esas condiciones, como el periodo puerperal o posparto, así como la menopausia, en el caso de ellas; en el de ellos, los relacionados con la andropausia, la pérdida del estatus o la separación marital.
Todos contamos con cierta

vulnerabilidad para desarrollar algún problema de salud mental: uno de cada dos individuos en algún momento de la vida lo va a presentar, alertó Coronel Manzo, y así se constató, en especial, durante la pandemia, por lo que es importante mejorar nuestras prácticas de autocuidado, desarrollar herramientas de adaptación ante entornos cambiantes y demandantes, y expresar lo que sentimos para recibir ayuda oportuna.
Además, se debe eliminar el estigma que persiste en torno a las enfermedades mentales, producto del desconocimiento. El rechazo hacia el enfermo ha ocurrido a lo largo de la historia; se le relega cuando lo que se requiere es brindarle ayuda por parte de la sociedad, recalca. El universitario aclara que la salud mental se refiere al adecuado funcionamiento, a nivel biológico, psicológico y social de una persona, de modo que sea funcional y productivo para su sociedad y capaz de alcanzar sus metas.
SE PIERDE PRODUCTIVIDAD
En 2024 el Día Mundial de la Salud Mental lleva por tema “La salud mental en el trabajo”. Al respecto, Diego Coronel destaca que un individuo es más eficiente si tiene una adecuada salud mental y si hay respeto
en los horarios laborales. Empero, presenta problemas cuando las jornadas se extienden y en lugar de desempeñarse como máximo 48 horas a la semana, lo hace 55 o 60. Y cuando además el jefe tiene dificultades para comunicarse, hay poca eficiencia para resolver conflictos o escasa claridad respecto a las tareas que debe desempeñar cada uno dentro de la organización, detalla.
“Vemos una mayor tasa de incidencia del síndrome de burnout o del ‘trabajador quemado’, con fatiga crónica, insomnio y hasta depresión en los entornos laborales debido a que no se permite que haya un tiempo adecuado de descanso y recuperación. Esto, por supuesto, repercute en la funcionalidad del individuo y en su entorno de trabajo y no es beneficioso para la organización o la empresa, ya que se pierde productividad”, indicó el académico.
De acuerdo con la plataforma Statista, de 38 países analizados por la Organización para la Cooperación y el Desarrollo Económicos los mexicanos son los que más horas pasan en su puesto laboral, un promedio de dos mil 226 al año. Le siguen Costa Rica, dos mil 149; Chile; mil 963, y Corea del Sur, mil 901. Estas cifras contrastan con
Japón, mil 607; Reino Unido, mil 532; Francia, mil 511, y Alemania, mil 341. Además, si el trabajador labora demasiadas horas y no goza de tiempo para su disfrute personal y, por ende, su calidad de vida disminuye; la retribución que recibe es menor en comparación con otras naciones. Todo ello predispone al desarrollo de diferentes malestares emocionales, incluida la insatisfacción por el trabajo y la frustración por el desempeño, que más adelante se transforman en un trastorno mental, advirtió el experto.
Según el universitario, en las organizaciones se requiere un servicio de apoyo psicológico, de acompañamiento psicoterapéutico breve y tratamientos preventivos, antes de que empiece a mermar la productividad y se registre, incluso, la baja de la persona empleada. Para mejorar la situación, la educación y la información son lo más relevante. Los jefes tienen que conocer la importancia de la salud mental y las pérdidas que se generan al haber casos de enfermedad, en tanto que el colaborador debe establecer “factores protectores” como el autocuidado, y marcar límites, respetando horas de sueño y de comida, realizar actividad física, etcétera.
La actriz aseguró que las acusaciones de violencia que ha recibido su prometido no cambian sus planes.
El actor británico de 81 años, conocido por su papel de Gandalf en El señor de los anillos, se vacunó contra el coronavirus.
El actor británico de 81 años, conocido por su papel de Gandalf en El señor de los anillos, se vacunó contra el coronavirus.
La famosa cautivó a sus seguidores de Instagram con una fotografía de su pasado.
grama Sale el Sol, Martha Cristiana confesó que decidió hacer pública su experiencia porque sigue padeciendo los estragos de su matrimonio con Martínez Ostos.
pretó al mago Gandalf en las películas de El señor de los anillos, dijo que estaba eufórico después de recibir su primera dosis de la vacu na contra covid-19 de Pfizer. Además, pidió dársela a las personas a quienes se la han ofrecido.
pretó al mago Gandalf en las películas de El señor de los anillos, dijo que estaba eufórico después de recibir su primera dosis de la vacu na contra covid-19 de Pfizer. Además, pidió dársela a las personas a quienes se la han ofrecido.
prendiendo en redes sociales por su carisma y divertidos videos. Con el título de la Reina de TikTok en su poder, la actriz no deja de publicar clips en los que aparece bai lando graciosas coreografías, imitando a otras celebridades o recreando escenas de la televisión. En esta ocasión, la famosa cautivó a sus fans con una fotografía de su pasado.

Salud (NHS), entidad que está llevando adelante el programa masivo de vacunación de coronavirus en el Reino Unido, publicó varias fotos del actor británico, vestido con una playera azul y una bufanda multicolor, levantando el pulgar al recibir la inyección.
Salud (NHS), entidad que está llevando adelante el programa masivo de vacunación de coronavirus en el Reino Unido, publicó varias fotos del actor británico, vestido con una playera azul y una bufanda multicolor, levantando el pulgar al recibir la inyección.
tantas agresiones, siempre pasivas agresivas y siempre estas ganas de verme débil, siguen pasando muchas cosas. Yo me he callado miles de veces, yo me he callado miles de cosas por proteger justa mente las cosas maravillosas que pasamos juntos, nos casa mos por la iglesia, tuvimos dos hijos, y ahora se va a tratar de desacreditar esos 16 años que pasamos juntos… ¿tanto coraje me tienes nada más porque te pedí el divorcio?, porque no te pinte el cuerno, no te dejé en la calle”.
Buenfil tiene proyectos tele visivos en puerta, la actriz reconoció que entró en depresión hace unos meses tras perder la exclusividad en Televisa, pues había trabajado por más de 40 años en la empresa. La famosa había protagonizado exitosas telenovelas, en donde no sólo la audiencia quedó impresionada por su interpretación sino también por su belleza.
Érika Buenfil se une a la fiebre de “Tusa”
“Es un día muy especial, me siento eufórico. Me siento muy afortunado de haber recibido la vacunación. Realmente espero que, a medida que más personas se vacunen, avancemos en el camino de regreso a una forma de vida más normal”, dijo McKellen, de 81 años. Casi 140 mil personas han recibido la primera
Al respecto, Ana Serradilla declaró que le parece triste que, a pocos días de su boda, Martha Cristiana revele estos pasajes de su vida y más aún cuando su matrimonio con el empresario terminó hace cinco años.
Érika Buenfil inició su carrera en la televisión desde 1977 con pequeños papeles en telenovelas como Acompáñame, La llamada de tu amor y Lágrimas negras. Sin embargo, nunca antes la actriz había publicado una
“Es un día muy especial, me siento eufórico. Me siento muy afortunado de haber recibido la vacunación. Realmente espero que, a medida que más personas se vacunen, avancemos en el camino de regreso a una forma de vida más normal”, dijo McKellen, de 81 años. Casi 140 mil personas han recibido la primera
“Fue fuerte y un poco triste porque este divorcio se dio hace cinco años aproximadamente y tener estas declaraciones fue como ‘Wow, justo a días de la boda’, pero bueno, todo pasa por algo y yo no puedo ni juzgar ni nada, Raúl sabrá cómo manejarlo y cómo
resaltó que es muy delicado hacer juicios o hablar de algo que no le consta, porque lo único que ha recibido de su prometido desde que lo conoció son buenos tratos y mucho amor.
La actriz compartió en TikTok un video en el que utilizó el audio de la canción “Tusa” en versión bachata para realizar un clip que rápidamente acaparó la atención.
“Es muy delicado emitir juicios porque no conocemos la otra cara de la moneda. Yo por eso trato de mantenerme al margen porque es un tema bien delicado, cualquier cosa que yo diga no aplica en este caso”.
nica en difundir que recibió la vacuna de covid-19, parte de un esfuerzo colectivo por llevar tranquilidad a la población con dudas sobre su seguridad. No se sabe si la reina Isabel, de 94 años, y su esposo, el príncipe Felipe, de 99, ya han recibido la vacuna. La monarca es muy respetada en el Reino Unido y su apoyo daría un mensaje poderoso para contrarrestar la desinformación sobre la vacunación.
nica en difundir que recibió la vacuna de covid-19, parte de un esfuerzo colectivo por llevar tranquilidad a la población con dudas sobre su seguridad. No se sabe si la reina Isabel, de 94 años, y su esposo, el príncipe Felipe, de 99, ya han recibido la vacuna. La monarca es muy respetada en el Reino Unido y su apoyo daría un mensaje poderoso para contrarrestar la desinformación sobre la vacunación.
En el video se observa a la actriz tomar un objeto adornado con una rosa el cual ocupa como micrófono, también Érika usa unos audífonos para simular que se encontraba en medio de un estudio de grabación cantando el tema que hizo famoso Karol G.
Cada año, los productores mexicanos de música electrónica dan un nuevo paso hacia la conquista internacional, en 2019 Tom & Collins entraron por primera vez al top 100 de Dj Mag, la revista británica con uno de los listados más importantes a escala mundial, mientras que Le Twins tocó en el aclamado Tomorrowland, ambos duetos celebran el crecimiento de la escena mexicana.
Sin embargo, esta convencida de que estas declaraciones no pueden distraerla de su principal propósito que es celebrar su boda: “Claro que sí, yo estoy muy feliz con el próximo evento”, recalcó.

En entrevista con M2, sentados en un LooLoo Studio que luce vacío, pues es media mañana y la fiesta aún no comienza, Jorge Corral y Juan Pablo Escudero, mejor conocidos como Tom & Collins, tocan el hilo que se debe seguir: “Este año le dimos con todo para poder entrar (al top 100), más por el hecho de que más ojos se pongan en lo que está pasando en México y en Latinoamérica, que por algo
personal”.Jorge agrega: “El gremio mexicano está en un momento crucial, cada vez hay más mexicanos en festivales y está creciendo rápido ese número, nos da muchísimo gusto ser parte de esa ola. Cada vez hay más gente volteando a ver a México, tanto por nuestra música como por cómo consumimos electrónica, por el apoyo del fan mexicano, que es mucho más comprometido que en otro lugares”.
Los dj y productores nacionales trabajan en múltiples géneros, hay para todos los gustos; sin embargo, no siempre reciben el apoyo debido dentro del país. El extranjero es quien los ha arropado, pero ellos, dicen, quieren contar con su casa, ya hay trabajo de años y la calidad necesaria, solo es cuestión de abrirse a nuevas opciones.
Billie Eilish hace lo que nunca: se quita las capas de ropa y muestra su cuerpo
La cantante lanzó un video en el que además confronta a la gente que critica su cuerpo
El nuevo filme se centrará en la historia de un personaje femenino eintroducirá nuevas referencias en este universo fílmico.
Son numerosos los talentos, por mencionar algunos nombres se tiene a Brain Hunters y Mr. Pig, quienes han tocado en Tomorrowland; Héctor ha puesto a bailar con su techno y house a Berlín e impulsa su sello Vatos Locos, mientras que Oscar Velázquez ha viajado por América, Europa y este mes llegó a Tailandia.
Esta vez decidió dar un giro total a su exigencia presentando un video en el que, mientras expone su punto de vista, se va quitando la ropa.

» SABOR LATINO
Esto ocurrió durante el intermedio de uno de los conciertos que ofreció en Miami como parte de su gira Where Do We Go?.
En el clip, que dejó a más de uno con la boca abierta, la cantautora mira a la cámara mientras enfrenta a quienes han criticado su físico.
PODER FEMENINO
Margot Robbie será la protagonista de una nueva entrega de Piratas del Caribe que seguirá las aventuras de un personaje femenino con una trama totalmente diferente de la película original. La exitosa saga comenzó con las aventuras del capitán Jack Sparrow, un emblemático personaje que interpretó el actor Johnny Depp, quien quedó fuera del proyecto tras el escándalo mediático que mantiene con su ex esposa Amber Heard.
“¿Te provocan mis hombros? ¿Y mi pecho? ¿Soy yo mi estómago? ¿Mis caderas? El cuerpo con el que nací, ¿no es el que querías? Si llevo lo que me es cómodo, no soy una mujer, Si me quito las capas, soy una pu** y, aunque nunca has visto mi cuerpo, tú lo juzgas y me juzgas a mí por él”, dice Billie Eilish en este controversial video.
Karen y Karla de la Garza, mejor conocidas como Le Twins, aprovechan para hablan de las mujeres en la industria, pues se están coronando, como lo demostró Mariana Bo en el reciente año que terminó, al llegar a la posición 49 del top 100 de Dj Mag, dejando atrás a figuras como Zedd, Alesso, Claptone, Diplo y Steve Angello.
Según la revista The Hollywood Reporter, este proyecto de Disney y Margot Robbie no tiene nada que ver con la anunciada nueva versión de Pirates of the Caribbean en la que está trabajando Craig Mazin, el creador de la aclamada miniserie Chernobyl.
Al final del mismo, la cantante nacida en Los Ángeles de 18 años se queda en brasier como una forma de protesta, pues también pregunta al espectador si le gustaría que fuera más pequeña o más débil, más suave, más alta o más callada. “¿Mi valor se basa sólo en tu percepción o tu opinión sobre mí no es mi responsabilidad?”, se pregunta.
“Hace unos cinco años no había tantas mujeres como
ahorita, es bonito ver cómo está creciendo. Por ser mujeres a la gente le entraban dudas, pero luchamos por demostrar que la música no es cuestión de géneros, es cuestión de creatividad; cada crítica nos da impulso, de crecer y demostrar el triple de veces que ser mujer no determina si eres peor o mejor”, destacó Karla en entrevista con M2. Karen añade: “Como hermanas nos ayudamos muchos, nos recordamos todos los días que por más que digan, sabemos lo que podemos hacer (…) Diario recibimos mensajes de niñas que nos dicen que quieren ser como nosotras o que ya compraron sus primeros audífonos y entraron a clases; qué bonito ver ese proceso, ver que más mujeres se inspiran y pierden el miedo para hacer presencia en este medio”.
Los productores ven un lado positivo al boom del reguetón porque todo el mundo pone sus ojos en América Latina.
» EL EFECTO “Sí está en todos lados y está haciendo que quieran hacer cosas con latinos, lo vemos con nuestro house y tech house”, dijo Juan Pablo.
» EN ESPAÑOL
Tom & Collins lanzó “Malo” (ft. Jesús Navarro y Elsa y Elmar) y Le Twins “Dime la verdad” ante la demanda de letras en español.
» LA SORPRESA
“Estuvimos en India y China y nos llevamos la sorpresa de que los promotores querían que tocáramos en español”.



PRIMERA SECCIÓN
PRIMERA SECCIÓN Martes 04 de Julio de 2023
Viernes 18 de Octubre de 2024




El Heraldo de Tuxpan
Sábado 19 de Octubre de 2024

Tres jóvenes fueron atacados, tras ser perseguidos por sujetos armados quienes les dieron alcance en la Plaza El Chayote, en Coscomatepec.
¡SE SUICIDA!
Sin vida y en el interior de su recámara, fue localizado un masculino, residente de Córdoba. PASE A LA 22

CAEN ROBA TRÁILERES
Sostuvieron enfrentamiento contra agentes de la Guardia Nacional, en Cuitláhuac.
PASE A LA 23

VINCULAN A ERUBEY
Joven lanzó por los aires a un gatito, fue acusado de maltrato animal, en Coatzacoalcos. PASE A LA 23
